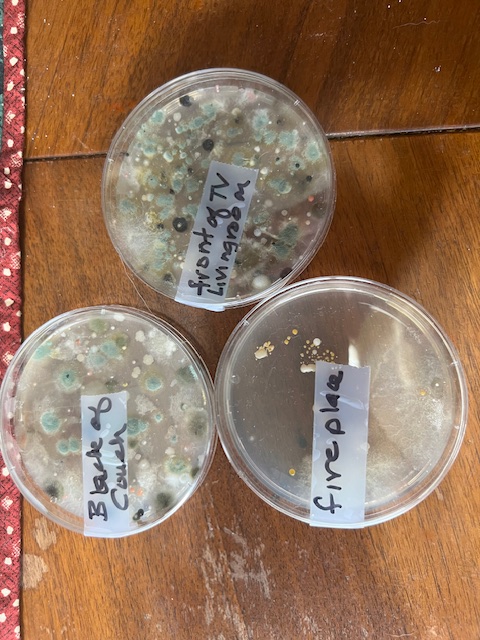
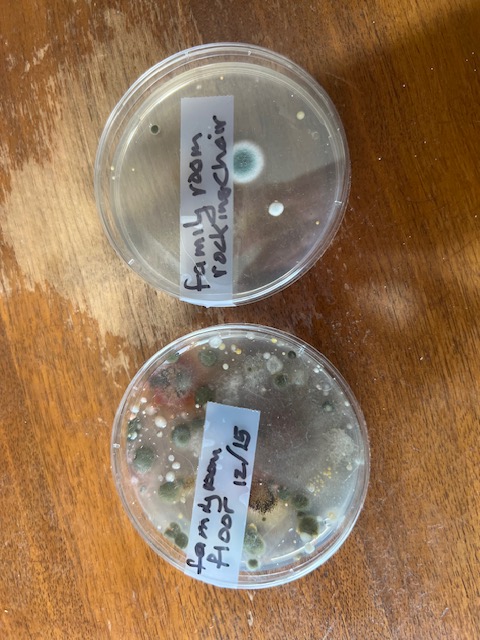

APRIL 2026 – Health teaches us that the simplest things are the most precious.
I keep waiting to post “I am so much better” but still sorting through what I hope will work and doesn’t. Always looking for new types of natural energy supplementation, or direction. Reading searching information what has worked for others health and stamina.
I am still taking the energy supplements I started taking last month which is positive. I don’t take a full dose but I am able to tolerate them. One doctor told me, “Sometimes a little is a lot more.” For me very true. Too much puts more stress on my system and I feel sick. I have to go slow. I know these supplement are good, I just haven’t yet felt sustained strength…but there are times I feel strong like I use to…especially at night. So the body is trying. I tell myself “I just have to be patient” hard when I feel like I have been sick/tired forever.
Strength is not a force – it is resilience. Resilience is key when searching for answers/solutions…I have found when I find something I hope will make a difference and it doesn’t…refocus as soon as I can… and I always find something or someone else for a new direction. Strength begins the moment you refuse to give up.
HYDROGEN WATER
I had seen this on the Internet and facebook, read others reviews … it wasn’t that expensive so I thought, “Why not give it a try.”

Benefits -Antioxidant Action: Molecular hydrogen acts as a potent antioxidant, helping to reduce oxidative stress—a factor linked to cell, tissue, and DNA damage.
Reduced Inflammation: Studies indicate it may reduce inflammation in the body, potentially helping to manage conditions like arthritis or metabolic issues.
Improved Athletic Performance: Research suggests it can reduce lactate buildup, decrease fatigue, and boost endurance, making it popular for workout recovery.
Cardiovascular Health: Some studies indicate it can help lower LDL cholesterol and improve heart health, such as decreasing cardiac hypertrophy and restoring vascular function in studies.


Brain Health: Emerging research suggests it may support brain health and recovery after trauma by reducing neuroinflammation.
Metabolic Support: It may help improve glucose tolerance and lipid metabolism, particularly for those with type 2 diabetes or insulin resistance
So after researcing I bought some hydrogen tablets. They were 3rd party tested, a reputable company with good reviews. I drank my hydrogen water first thing in the morning. After a week I started feeling more tired, sleepy, and then anxiety for no reason… 2nd week –then came the anxeity/panic attacks…I had several one morning and for two days until it got out of my system. So I stopped the hydrogen tablets and no more attacks and more level of energy came back…so that didn’t work for me! If I ever decide to try it again I will take 1 tablet every 3 days.
This is what CHATgpt said:
Hydrogen affects: Can overlap with autonomic dysregulation – which is a malfunction of the nervous system which controls involuntary bodily functions like heat rate, blooe pressure, digestion and temperature.
In sensitive people, this may temporarily shift:
- blood pressure – Yep, and my blood sugar
- circulation
- sympathetic/parasympathetic balance
That can feel like:
- internal adrenaline
- panic attacks – Yep, that’s me
- chest tightness
- wired-but-exhausted feeling – Yep!
- sudden fatigue – Yep!
Especially if taken in the morning when cortisol/adrenaline systems are already naturally rising.
Overstimulation of a sensitive nervous system
Hydrogen is often marketed as calming, but some people paradoxically feel:
- overstimulated
- anxious
- emotionally activated
- “revved up” Yep all of the above
This can happen in people with:
- chronic fatigue syndromes – That’s me
- high oxidative stress adaptation
- sensitive autonomic systems – Me
- sleep disruption
- neuroinflammation
- Nervous System Adjustment: While hydrogen is generally seen to lower stress, a small number of users report lightheadedness or dizziness, which can sometimes trigger or worsen anxiety in sensitive individuals.If the reaction reproducibly returns, your system is probably sensitive to the physiologic shift it creates. Yep…that’s me!
Something to consider when taking Hydrogen water. Maybe start out real slow…If you try Hydrogen Water…start out slow…like every other day for a week or two.
According to CHATgpt I have Energy Cellular Disregulation….Obvously!!!
PEPTIDES:

Peptides are short chains of amino acids that function as signaling molecules to regulate key processes like metabolism, muscle growth, and tissue repair. Benefits include boosting collagen for skin health, reducing inflammation, accelerating muscle recovery, supporting weight loss , and enhancing immune function. I listened to a podcast on peptides and all the positive results with people who were using them.
The best peptides for increasing energy depend on the root cause of fatigue, with MOTS-c (mitochondrial function), and NAD+ (cellular energy) Just started NAD.


Peptide – Methylene Blue -Enhances Cellular Energy (Mitochondria): It acts as an electron cycler, taking electrons from NADH to cytochrome c in the mitochondrial electron transport chain. This improves production (cell energy) and reduces reactive oxygen species (ROS), acting as a powerful antioxidant. I took this about a week and there are some risks and side effects so since I am so sensitive to everything, I decided to wait to hear back from my naturepathic doctor.

Sinus infections is one of my systems weaknesses – I got one this month…so tired and bad migraine headache!! For ten years I was plagued with chronic sinus infections. Always on antibotics…it seemed like every other month I was getting them. In the course of five years I ended up having three sinus surgeries…each one worse than the one before. Even after the surgeries I was still getting infections. After the third surgery…I said, “No more!!!” As it wasn’t helping. In doing some research I started steam bathing with the herbs thyme and oregano or peppermint everyday for 15-20 minutes for four months. Then every three days for a year. It killed whatever bacteria was causing the infections. Occasionally I will still get a sinus infection usually around once a year. Sometime I don’t even have to have a cold…my sinuses get inflamed and don’t drain. Because I can’t smell since covid, I can’t smell the infection smell and start getting the sumptoms of feeling sick and extremely time and nausous, headache, eye ache. That’s when I have to use an antibotic.

Now if I get a cold I steam bath right away and my sinuses don’t become infected. The oils reduce the inflammation so my sinuses can drain. Oregano is an antimicrobial, anti- inflammatory and anit-viral properties. Thyme – Antifungal, anti-inflammatory, an antibacterial. Peppermint is a Antimictobial – fights bacteria. It’s a BIG WIN!!!!!!
APRIL ACTIVITIES
The beach was so nice this day and beautiful and gives my soul peace:) Lots of driftwood for sitting!


Spring Beach Flowers



April’s Sunsets…Aways a different color schemes…



Always look forward to watching Mackenzie’s games…she has had several home runs this season! She is a busy young lady playing South Coast Club ball and Varsity Softball.





Winchester Bay has so many beautiful places …always changes with the weather, the sun, the clouds, and the time of day.







“You may have to fight a battle more than once to win it” – Margaret Thatcher. This is my story. Every day, every week, every month. It seems there is always something else I am dealing with…a new food sensitivity, over all body weakness, not getting a good nights sleep, etc. However there are some battles that I don’t have anymore! Life is always changing, problems come and go, it is how we handle our difficult times that make us stronger. Attitude is a little thing that makes a big difference, it determines our mental state, whether we choose to be happy and look for answers or we sit and complain. Happiness is not by chance but by choice.
No matter what we are dealing with attitude makes all the difference, not always easy but is our key to happiness. Summer is here…enjoy the sun, take a walk, run, ride a bike, go somewhere you’ve never been, meet up with friends, hike some trails, exercise, just be active, read a great book, and create opportunties. See the good and keep moving. Tomorrow is another day…great things may happen!!
MARCH 2026 – It’s not until you get tired that you see how strong you really are.

So very true… Never in my life would I ever have thought I would have this level of fatigue . When for the majority of my life I had more energy than most. Running in the mornings 4-5 miles before work would energize me and give me energy the rest of the day; on the weekends 8-9 miles, lifting weights, biking…etc There’s a reason my now energy is not at a proficient level of functioning ...and I am going to keep trying until I found the reason, fix it and see results!
March was a hard month as still recovering from the chelation infusions. I feel because it was an agressive detoxing mycotoxins/ heavy metals detoxing protocol, the body was working hard to rid itself of these substances…hence the hives…overload for the liver and kidneys. I am very tired and more sensitive to foods and supplements now. I still walked every day, jump on my rebounder. This helps to drain the lymph glands, liver, and kidneys…all things I and everyone need. Resistance weights for strength and stretching to stay limber. Afterwards I am exhausted but in the long run I will be healthier for it.
What do your blood pressure numbers tell you…It consists of two numbers: systolic (top), measuring pressure when the heart beats, and diastolic (bottom), measuring pressure while the heart rests between beats
After chelation because I felt so tired I started checking my blood pressure and blood sugar in the morning same time before I ate .
My blood pressure, which I have always had low blood pressure, was 80/60, 103/57 (bottom numbers way too low, should be higher 70s-80), then some days up to 104/76 (which is much better)!! Up and down...No consistency. Wondering if the inconsistency in my blood pressure/sugar are causing some of the fatigue????


For my age, normal fasting blood sugar is generally 80–130 mg/dL. Blood sugar the lowest was 57( way low…so I had a spoon of honey). One day blood sugar would be too low then the next day normal then low again...Also no consistency. After excersise my numbers were always better, more stable. So I needed to watch what I was eating in the morning – juice or honey if the blood sugar too low. Frustrating… Hoping in April my system will level out and stablize.
LOW ON MINERALS AGAIN!!
Even though I had 3 remineralization infusions, the last one in the middle of December, my mineral levels were way low again. Ordered several minerals…zinc, copper, trace minerals, Multi-mineral Complex, and Metagenincs 360 Untrainflam X Plus 360 (this supplement has helped more than any other and contains 40 essential minerals) Thankfully after a week I started the minerals I was feeling better. I have a tendency to take supplements then when I feel better and I think, “OK, now I don’t need this anymore.” However, it’s going to be a continued supplementation.
Minerals are essential nutrients that fuels the body’s growth, development, and daily functions.

Metagenincs 360 UltrainflamX Plus 360 which contains 40 essential minerals, I purchase it from one of my doctors, but Amazon has it.


Mineral Key Roles:
Bones & Teeth – Calcium, phosphorus & Magnesium
Muscular and Nerve function – Potassium, sodium and calcium
Fluid Balance – sodium and chloride
Oxygen Transport and Energy Production – Iron…vital for hemoglobin to carry oygen througout the body.
Immune System – Zinc, copper, and selenium.
Macrominerals -Require larger amounts – Calcium, phosphorus, magnesium, sodium ,potassium, chloride, and sulfur.
Traced Minerals – Require less amounts – Iron, manganese, copper, iodine, zinc, cobalt, floride, and selenium.
All have an important function in our system. They are life-sustaining compounds that are present in our soil and water. We cannot produce them so we have to get them from other sources…plants and animals. The Mineral Chain… from plants absorbing the minerals from the soil; then the animals get their minerals by eating plants, fish from the water…so they are not only essential for our system to function and be balanced but also for the balance in nature.

Energy producing supplementation
Mornings are still my tired time until around 1:00 or so… I did a zoom with my naturopathic doctor, she also prescribed the following energy building supplements. Trying each supplement one at a time. I do 1/2 capsule one at a time. Now up to 1/2 of three of the energy boosting supplements daily
Acetyl-L-Carnitine – is a compound that supports energy metabolism and brain health by crossing the blood-brain barrier.
Jarrow Formulas – QH-absorb 100MG – provides superior abasorpton of the active, antioxidant form of CoQ10, boosting plasma levels by up to 777% in 14 days. Supports cardiovascular health, increases cellular energy (ATP) production and protects cells from oxidative stress.

Creatine Monohydrate Powder – increases muscle mass, strength, and high-intensitry exercise performance by boosting ATP energy production.
Protocol – Taurine 1000mg – is an amino acid that supports cardiovascular health, metabolic function, and the nervous system by aiding in hydration, electrolyte balance aid in exercise performace , and provide antioxidant/anti-inflammatory benefits.
WELLNESS IS A CONNECTION OF PATHS; KNOWLEDGE AND ACTION
Every supplement, pill, powder or liquid I take I read what does it does for the body, the benefits and the cautions. Then I have to start slow. Some I don’t react to, some will make me feel anxious, some I feel like I am going to jump out of my skin, and some make me sleepy and tired…so I have to go slow. I would love to feel enegetic with sustained strength…that’s the goal….it is work & still working on it!!!
I was doing OK taking 1/2 of three of the supplements per day for a couple of weeks. Then I got a sinus infection…so now starting again…frustrating….fingers crossed I will be able to see and feel some positive results.
Heat therapy – turn up the tempetrature
In Dr. Hyman’s book, Young Forever, “Scientist did a study of 2,000 Finnish sauna users over 20 years The average temperature in the saunas is 174 degrees fahrenheit. Those who used a sauna 2-3xs a week had a 24% lower risk of death; hard core users 3-7xs a week had a 40% reduction in death. Advantages – improves heart rate variability, insulin sensitivity, blood sugar and blood pressure levels. Any type of heat therapy works, including saunas, infrared saunas, steams, hot baths, hot tubs, hot springs, and hot yoga”.


They are kind of expensive, but if you have handy-man around the house it would be much cheaper. They are between $2,500-$4,000+ all depending on how much you want to spend. They are a round the same price as hot tubs…You can also use a sauna blanket($100-$400) or a small protable solo infrared sauna($150-$250). Another option is steam shower that can be installed in most home showers…These are more expensive $15,000. I looked on Amazon for the pricing.
I sit in my hot tub most every night; 8:00pm for 25 minutes at 103-104 degrees. I have more energy afterwards then I have all day. I feel normal…not tired. For me…It is very relaxing and I LOVE the heat! (that’s why I go to bed around midnight…LOL)


Benefits of Heat therapy – improves insulin sensitivity, blood sugar and blood pressure, increases endorphins for a natural high and reduces stress hormones and improves sleep. It helps with depression, weight loss and detoxification. A sauna therapy four times a week reduces the risk of dementia and Alzheimer’s by 66 percent! WOW! Heat therapy boost growth hormone needed for repairing and rebuilding your tissues, joints, skin and hair! Saunas help our immune system, fights infections and cancer and reduces inflammation. Who doesn’t NEED ALL OF THESE BENEFITS!!!!
MARCH ADVENTURES
A Foggy evening in Winchester Bay…the fog muffles the sound… no wind…it was a very quiet/silent evening. Nice



Carter Lake Trail – fun trail to walk, it is not too far to the overlook and if you are adventurous, you could walk a trail to the beach and back; probably 8 miles in all…not a bad hike!!!



Below is Devils Punch Bowl which I wanted to walk down into the punch bowl and take pictures…but it was late and we’d been in Lincoln City most of the day and wasn’t sure about the tide; I didn’t want to get trapped inside…So another day!!! Thor’s Well is always spectacular!!! People amaze me of how close the get to the edge…especially Thor’s Well. Every once and a while a drowning occurs.






March had several wonderful colorful, no wind sunsets….They are all my favorites!!! I love to see what amazing sunsets at Winchester Bay and the beach ...always different…light combinations, sun color, cloud formations, wind or no wind...the sound of the surf is always relaxing. A beach fire would be awesome…signs say no fires; however, there is evidence of many fires…LOL. Years back we would have fires on the beach while night crabbing off the crab dock.…Fun Times!









This evening was very windy..I was getting sand blasted…lol!!!!!



Spring in the mountains!!!! There are many bright, delicate wild flowers…signs of new growth…summer is coming!! Elk are happy to be out warming themselves in the sun!! Some hill sides are covered with flowers.






My challenges for summer.
- I want to ride my bike , feel well enough to tube on the lake, go on hikes, build on the exercise I am already doing and ride/drive our polaris.
- Keep learning and reading – personal health/ nutrition, and mental health.
- Continue to help others with who also suffer with health issues.
My advice would be never ignor when your body gives you a symptom something is not working right... pain, inflamation, fatigue, poor digestion, soreness, headaches, rashes, insulin resistance, etc…Many times it starts small and you hope it will just go away. My experience…it doesn’t. You may have the symptom for many years…before it becomes debilitating. Do your research. Find out the “whys”, the “whats”, the “hows” to get better and reverse the illness. Research what supplements and herbs may help and most important what foods will strengthen and heal you.
There is no eating pecan pie or chocolate chip cookies for breakfast anymore…something I use to do…unfortunately sugar is the worst food for your health.
REMEMBER – WELLNESS IS A CONNECTION OF PATHS; KNOWLEDGE AND ACTION – It takes time, knowledge and work. Have a great and healthy rest of April!
FEBRUARY 2026 – Resilience is knowing you are the only one that has the power and the responsibility to pick yourself up. You may have to fight your battle more than once to win it…

YAY…THE HIVES ARE GONE!!!
The month of Februrary has been a hard one. Trying to recover from the three months of chelation infusions left me beyond exhausted. Reacting to items I have used for months/years… it’s a guessing game which or what .My system is also more reactive when I detox. Just because you buy a product from a “health food store” does not mean it is healthy. For example, I bought a container of blue berries...I would eat them in the evening. During the night and in the morning I would feel nauseous. and tired. After several days of mentally searching and eliminating, and through bio-kinesiology discovered it was the blue berries. You never know where they were grown (could be right by a highway being covered with fuel exhaust fumes) or grown with a fertilizer that wasn’t organic…etc…there are many reasons why some foods are not always organic at the Organic Section.
I have an App on my phone Yuka. You scan the bar code of an item and it will tell you if it is Excellent, Good, Fair, Poor, or Bad. Helps a lot when I am buying oils, breads, crackers, chips, dips, yogurts, Kumbacha drinks, anything not fresh. Also for non food items, such as soaps, shampoos, conditioners, chapsticks, make up, etc…. Very Helpful!!! READ YOUR LABELS…IF YOU CAN’T PRONOUCE IT …DON’T EAT IT!!


YUKA -Good
Also this month I though I was washing my sheets/bedding in a healthy “clean” soap, borax. Then I kept waking up with sinus, itchy eyes, and very tired in the morning…so I washed the bedding 3x in white vinegar and baking soda. Now the bedding is fine. I know this sounds crazy/psycho, but this has been my life since I was 25.
DID YOU KNOW…
All new clothes – All wrinkle-resistant item have a toxic treatment applied to them – formaldehyde resin. This chemical is used to keep garments looking freshly pressed, non mildew, and inhibitpest growth during long-distance shippping. The “New Clothes” smell – the sharp odor often associated with new clothing is the odor of formaldehyde. Besides formaldehyde, clothes are also treated with color-fasteners, softeners, and stain/water repellents (often PFAS or “forever chemicals”) These “forever chemicals” do not break down easily and contaminate our water, soil, linked to cancer, liver damage and immune system failure. Now we are wearing them and smelling them all day long. Scary!!! There is a lot of information on the Internet.
I wash all my new clothes 4x before I wear them. I learned this in 1977 when I was going to a Homeopathic doctor in Eugene (this was before the Internet) and chemical exposure awareness was just beginning. I went to classes three days a week for two weeks learning the Do’s and Don’t of how to “Live in a chemical world.” Cotton sheets, blankets, pillows, clothes (keep the bedroom free of any chemicals at night while you sleep), water filters, organic foods, etc…….I also have to sleep in white sheets, and blankets as colors dyes gas out odors.


SOAK ALL NEW CLOTHES IN BAKING SODA – in a mixture of baking soda for several hours or overnight to neutralize the chemicals. You can also hang in fresh air or sunlight for 24-48 hours to “off gas” before washing.


DID YOU KNOW
YOU SHOULD WASH NEW BED SHEETS, BLANKETS, ETC at least 4-5 times with 1 cup baking soda and 1/2 cup vinegar before you use them.
Bedsheets are treated with formaldehyde for wrinkle resistance, PFAS ((perfluorinaterd compounds) for stain/water repellency, and AZO dyes for color, and flame retardants, Boric Acid/Antimonky Trioxide which can cause skin irritation, respiratory issues. (AZO can cause side effects, dizziness, stomach suset, and other serious risks…kidney/liver damage, and is apotential carcinogen) No wonder they made me sick until I washed them…!!!
HAZARD SUMMARY – Antimony Trioxide

- Antimony Trioxide can affect you when breathed in.
- Antimony Trioxide should be handled as a
CARCINOGEN–WITH EXTREME CAUTION. - Contact can irritate and may burn the eyes and skin and
cause an itchy skin rash. - Exposure to Antimony Trioxide can irritate the nose,
mouth, throat and lungs causing cough, wheezing and/or
shortness of breath. - Antimony Trioxide can cause headaches, poor appetite,
nausea, vomiting, dry throat, and loss of sleep. - Prolonged or repeated contact can cause ulcers or sores in
the nose. - Repeated exposure can affect the lungs and cause an
abnormal chest x-ray to develop. - Antimony Trioxide may damage the kidneys, liver and
heart.
If you want more information the link below is a HAZARDOUS FUNCTION FACT SHEET on Antimony Trioxide. SCARY!
https://www.nj.gov/health/eoh/rtkweb/documents/fs/0149.pdf
WASH ALL BEDDING AND BLANKETS, BEDSPREADS…I started doing this when I was 25 as I would get sick when sleeping in new bedding and wearing new clothes.
Even the natural fibers you have to wash out the treatments…Best for your health to wear nature fibers, sleep in natural fiber (cotton, linen, flax materal-untreated) before I sleep in new sheets I wash them 7 times. Most soaps leave a residue and many have perfumes odors, as well. After having three sinus surgeries, I can’t smell oders. Then after Covid I lost all smell. Some has come back… I have to ask Steve to smell for me…LOL
Since my infusions I have really been even more aware of the scary/disastrous effects of toxins/chemicals we breath, eat, absorb…live with on a daily basis. I never want to do heavy metals/toxcity chelation again. So I have “upped my game” on chemical awareness. Our systems are over loaded with these chemicals on a daily basis. Our systems are as strong as our weakest link…we don’t know what that is until we “CRASH”. Chemicals/toxins affect each person different. Some is fatigue, some sore joints, poor digestion, weight gain, organ failure, auto immune diseases, cancer…etc. There are lucky people who have stronger detox sytems and show no symptoms…yet. Lucky you!!! The next several paragraphs are an awareness of just a small portion of the chemicals we come in contact with every day in our home.


Scary to think more than 84,000 million new chemicals have been introduced into commerical products and have found their way into our water, soil/food, air since 1900. This includes pesticides, hervicides, plastics, bisphenols, aromatic hydrocarabons and heavy metal including arsenic, lead, and mercury. These are found in home-cleaning and personal-care products, prescriptions medications, lawn-care products. Many mattresses and bedding products are treated with flame retardantrs or contain fire-resistant materials to meet safety regulations….you can google it. My futons (fire resistant chemicals) has been making me sick, so out they go…!!!


Polyfluoroalkyl substances PFAS (man made “forever chemical” used since the 1940s to make products water, grease, and stain-resistant) These do not break down easily and contaminate our water, soil, linked to cancer, liver damage and immune system failure. PFASD is also non-stick cookware teflon. I use stainless steel and cast iron,and I have used glass in the past for cooking . PFASD in also in stainless resitant carpeting, cosmetics, and waterproof clothing. Exposure can cause increased cancer risk, kidney and liver damage, and high cholesterol.
Safe Cookware

Cast Iron Can Increase Dietary iron intake!

These toxins stress our system. Some are obesogens, environmental chemicals and substances that promote weight gain and fat accumulation by disrupting metabolism and endocrine function. Some are Autogens for their impact on autoimmune diseases and their ability to drive inflammation throughout our systems. Some toxins damage our DNA and our mitochrondira, alter our proteins, cause cells to age and exhaust our stem cells. They also damage our microbiome and cause leaky gut. I had a heavy exposure to DDT mixed with diesel when I was 3 years of age…hence my sensitivity to chemicals and processed food with additives.
NON-TOXIC SOAPS – These are the soaps I use that don’t bother me


Get a good water filter!!! For more information…Click on the link below to the water filter page on my blog.
https://lulushealthjourney.blog/2024/05/27/what-i-did-today-for-my-health-energy/
“Over the years I have tried many many water filters. Those of you who are lucky to live in the country and have well water, or spring water, LUCKY YOU! However, many of us are on city water. Maybe you buy water…hopefully it is pure and NOT in plastic, those on city water have chlorine and some also have floride. My system cannot take either one of these chemicals. In addition, our son who has constructed and repaired many city/residental water lines will NEVER drink city water. He saw first hand how much sludge,slime/debre sits in those water lines. Just not a few but all!” (quote from my link above)
Chemical byproducts produced by disinfecting drinking water with chlorine are associated with an elevated risk for both bladder and colorectal cancer, according to a new review published in Environmental Health Perspectives.
Common Contaminants and Components in water:
- Lead: Enters through old, corroding service lines and pipes. ( I had lead and mercury)
- PFAS: Widespread “forever chemicals” found in water for over 143 million Americans.
- Nitrates: From farm fertilizer runoff and wastewater.
- Disinfection Byproducts: Created when chlorine interacts with organic matter.
- Heavy Metals: Arsenic, chromium-6, and other, often naturally occurring. (I had both in my system)
- Volatile Organic Compounds (VOCs): Industrial chemicals like benzene. (I had this in my system too)
- Microplastics: Found in many water system ( I also had microplastic)

Top Rated Water Filters by Type:
- Best Countertop (RO): AquaTru Countertop Water Filtration System is ranked highest for superior contaminant removal, high efficiency, and easy “plug-and-play” setup.
- Best Under-Sink (RO): APEC Water Systems Essence Series 50 GPD (ROES-50) is recommended for its reliability and comprehensive 5-stage filtering.E
- Best Budget Countertop (RO): Waterdrop G3P600 Reverse Osmosis System provides fast, smart filtration.
- Best Pitcher Filter: PUR Plus 11-Cup Pitcher is top-rated for ease of use and contaminant reduction.
- Best Gravity Filter: Travel Berkey is praised for its long-term, durable use. (I have a Berky)
- Best Faucet Filter: PUR Plus Vertical Faucet Mount
Most water, particularly groundwater, contains at least trace amounts of naturally occurring arsenic, as it is a common element in the earth’s crust that leaches into water sources. about half of tested wells have detectable arsenic, but most remain below the 10 ppb safety limit. Safety Limit…what does that mean???? When we lived in the Eugene area in 1955-1963 several wells were found with high enough arsenic to close down a school and the development of a housing subdivison my parents were developing. It took several years to find a water source with low enough levels. Our personal water was never tested when we lived there. There were not regulations on personal propery land owners water systems.
Our local water supply is right next to Highway 101, so all the exhaust and hydrocarbons from passing cars, trucks sift right into the lake. Then it is treated with chlorine. Many times my husband can smell the chlorine when he turns on the facet. WOW…don’t and can’t have that in my system.
We will come in contact with thousands of different chemicals over our lifetime, ranging from natural compounds to tens of thousands of synthetic, man-made substances. While over 160 million chemicals are known to humanity, roughly 40,000 to 60,000 are in daily commercial use, with many appearing in common household products, air, and water.
The challenge is to Eat Fresh, Eat Organic, Eat Clean. Keep your house Chemical Free as much as possible (use an air filter) Use natural fibers for bedding (that you have washed with vinegar and baking soda) and clothes. I have a leather couch and metal blinds…no curtians. We will be ripping up the living room carpet in a month and replacing with tile…getting rid of mold...it’s an on going process…


This post has been an awareness post. With so much disease and illness today I hope we can all be more aware and conscious of what are systems are exposed to. Our body is working so hard to rid off so many hazardous/ cancer causing chemicals. It’s a daily practice…you can do it…take it a step at a time:)
I’ve already had chemical and heavy metal “OVERLOAD” in my system several times. I am trying to keep my organs healthy and clean from chemical toxins. I will do WHATEVER it takes to achieve it!
FUN FEBRUARY! One of my favorite places is the beach…I could sit there for hours and watch and listen to the waves. I like to walk from from 1st to 2nd or 3rd beach and look for beach “treasures”.




Heceta Beach/Light House is another one of my favorite places. It was a really nice day and I love to walk the trails up to the Lighthouse and trail up above the Lighthouse…great view!!! It also has a great beach!






Love, Love , Love to see our Grand Granddaughter, Amelia…so cute, so sweet, and so fun…sad when it is time to leave…She grows so much each time we see her!!



Snow Day – We had some snowy/cold days in Reedsport, so I knew there would be some in the mountains. Wells Creek had enough to see its beauty and build a snowman!




In the spring when the weather gets warm enough and it has rained enough for lakes in the dunes…best place to sit and relax and let Tucker swim:)



Our Granddaughter, MacKenzie, plays on the Southcoast 18U Volleyball club. They have played several tournaments, winning their last tournament in Medford. Fortunately they LIVE stream it and we can watch it on our Flatscreen TV!!! Go Mackenzie!!! They will have a tournament in their home town this month…it will be awesome to watch in person!!!



Even though I was very tired this month (chemical & food senstivities always affect my energy)…there is always something to do that does not always require a lot of energy. Every day I have a 30 minute excersise routine. Important for me to be get outside(clears my mind) & go for walks, go to the beach, the mountains, the snow, see family, or just go for a ride. My hope has always been to give an awareness of unanswerd fatigue …there’s always a reason…it could be a chemical/toxin you come in contact with everyday. It’s been seven years of working on this… I’ve always said,”I’ll do whatevery it takes… “Winners never quit, an Quitters never win.” I just have to find the missing component in my system that is not making or allowing the energy to flow. I’m in it to win it!!! I have no other option…..
Have a Happy Healthy March!!!
JANUARY 2026 – “A healthy body is a reflection of a healthy mind.” Be stronger than your strongest excuse. Fitness is not about being better than someone else—it’s about being better and healthier than you used to be.

EXERCISE – THE MOST POWERFUL LONGEVITY DRUG
Exercise clears and refreshes the mind, gives oxygen to the brain, blood , muscles and organs. It is the key to unlocking the body’s regenerative and reparative systems, activates longevity, helps the bodys’ antioxidant systems, and impoves cognitive function and mood. Helps supports a healthy and diverse microbiome, reduces inflammataion, supports mitochondrial health and balance hormones. Helps detoxification, circulation,and lymphatic flow. KEEPS THE BODY STRONG AS YOU AGE!

Exercise has been a part of my life since in my early twenties when I started running. It helped me mentally as well as physically. I learned to appreciate all types of weather…it was never too cold, too hot, too rainy or windy not to run. I was a distant runner…running anywhere from 4 miles to 10 miles on Saturdays. Those 45 years running has helped me during these 7 years know how important it is to do something even it was only stretching. Slowly I have been able to add walking…slow at first. Two years ago I got a rebounder…helped me with my balance, and stamina, also helps drain the lymph glands…a must with toxicity. Mornings I never feel good; however, every morning I am outside on my rebounder rain, wind, frost, etc, jumping to 4 songs on Pandora. I have several resistance lifts as well. It’s the only way I am going to be strong/feel better. It may take months to rebuild from the Mercury, lead, tin, and several micotoxins, but I have to do everything I can.Exercise helps to improve muscle function and mass, improves blood sugar and insulin sensitivity.I am hoping with my weight routine it will help with muscle and bone strength (every other day). I know it’s the only way I’m going to get better. One of my favorite running quotes, “The body achieves what the mind believes.” When running I’d have expectations on my daily runs…if I added an extra loop, mile, hill…I knew I would/could and finish strong. I will do everything I can to get well!!


January and February are the months of recovery and healing from all the chelation infusions. I was so exhausted in December and the first couple weeks in January with the tonsillitis. Sometimes I feel somewhat stronger…have more stamina but most of the time I’m still very tired, especially in the morning until around 1-2 in the afternoon. However, some days I am tired all day. I still feel I am still over reactive to foods as I still have some hives; hoping the liver and kidneys recover from detoxing! Hoping by the end of February and for sure March will be the magic month of energy … energized movement! Energy to walk to the park, go to the store, ride my bike in the nicer weather, drive, look forward to going places without the anxiety of worrying if I am going to feel well enough.
BENEFITS OF NAD + Injections – NAD injections support cellular processess and overeall health.
I started NAD injection therapy a week ago.
- Increase Energy Levels: Boosts cellular metabaolism, leading to enhanced energy production and reduce fatigue. Most important!!!
- improved Cognitive function: supports brain health, improving memory, focus, and overall cognitive function.
- Enhanced Mood: Can elevate mood an reduce symptoms of depression, promoting mental well-being.
- Detoxification Support: Helps detoxify the body by assisiting in the breakdown and removal of harmful substances.
- DNA Repair: Aids in the repair of damaged DNA, supporting overall cellular health and longevity. Important too!!

Recommended dose is 5 units each week or 2 units twice a week...so since I tend to be reactive I took 2 units the first time. I felt a little nausous and weak for a minute or two…normal reaction. I waited a full week for the second, I took 2.5 units. This time I got very weak, light headed, and felt as if I was going to faint. I drank a big glass of water and laid down for an hour. After talking to the pharmacist she said that it was an unsual reaction…not a surprise. I might need to cut back even more, optional is five units, I would take only one. I’ll see what my doctor says. Might use a cream instead.

Per my request I got a GROUNDING MAT for Christmas…they simulate direct physical contact with the earth to potentially reduce inflammation, impove sleep, lower stress, and boost circulation. They work by transferring free electrons from the ground to the body, which decrease cortisol levels, reduce pain and accelerate muscle recovery. Users can experience benefits such as muscle relaxation and a calmer nervous system.
After doing the research I use it just before I go to bed for 20 minutes…NO LONGER…as can have mild side effects such as tingling, fatigue, headaches, or flu-like (detox) sensations as the body adjusts to the Earth’s electrons. (I fell asleep while my feet were on the mat for an hour…was exhausted with flu-like symptoms the next day…of course I did!
I still have some what of a sweet tooth…LOL My new favorite is strawberry banana ice cream…YUM! Since “we are what we eat” even my sweets are sugar free. Very easy to make… Put in blender: 4 cups frozen strawberries, 2 cups frozen sliced bananas, 1 cup yogurt (I use coconut yogurt) 1 cup milk (I use rice milk). 1-2 teaspoons honey. Blend until creamy. Pour into a glass container and freeze. Before you eat let sit on the counter for 30-60 minutes to thaw. Enjoy!! YUM!!

I LOVE MY HERBAL TEAS IN THE MORNING…
GREEN TEA – Since I don’t digest well or feel well (sluggish and tired) , especially in the morning I drink a couple different types of Teas. Within 30 minutes of waking I fix myself a mug of Green Tea. It gives me a lift and mental clarity…gives me the strength for my morning exercise routine as it provides a sustained energy boost, kickstarts metabolism for fat burning and enhances mental focus…just what I need! Green Tea is full of antioxidants, it aids in reducing inflammation, supports heart health by improving blood flow and regulates blood sugar levels. I need all of the above!


CLOVE & OREGANO TEA – In mid morning I drop 5-10 cloves and a couple dried sprigs(from my garden) of oregano in a small pan of water, boil for 5-10 minutes, let sit for 5, strain into my tea mug. Benefits of Clove and oregano tea is a powerful, nutrient-dense herbal infusion that is a natural antimicrobial, anti-inflammatory, and antioxidant remedy. Helps fight bacteria, viruses, and infections colds, coughs, bronchitis. It also aids in soothing the digestive tract. Very helpful since I wake up with a nausous stomach since the infusions.
Activities of January
The beach is always beautiful. Everyday, every hour is a different look. The clouds, lighting, reflections, big agressive waves, or calm sea…all has its beauty. It is my happy place. The dune lakes are beautiful as well. Tucker’s favorite winter swim place!! January we had wounderful weather…warm and many days with no wind!!!



Many times I wished I had a house over looking the ocean so I could see every sunset…they are amazing! January has so much color in the sky, and waves were agressive with the high tides. Fun place!! I do go to the beach a lot as it is only 5 minutes of our home, I go mostly in the evening when I have more energy. Sometimes I’ve just sat on a log and watched the sunset happened…very relaxing for me.



Steve and I went to Shore Acres… not real crazy waves but a beautiful place regardless. We weren’t able to see the Christmas display this year due to my toncillitis, so in January we just had to make a trip anyway! LOL



Love seeing the grandkids!!! Left is our Great-granddaughter, soooooo SWEET!!!…would love to see her more often!!! Right is MacKenzie, who plays for the South Coast Volleyball Club, they have had several tournaments, all away. The cool thing is they Live Stream the games so we can watch them on our television!! March their tournament is in Coos Bay… YAY!! Will be fun!! (hope to feel better) Bottom pic is anothergranddaughter Hailie with her little guy, met her down at the beach…we had a fun time catching up!!!!!



Getting your heath back is an everyday process. The system responds better the younger you are. If I would of have all the knowledge available when I was 25, I don’t think I’d be as sick/tired; a younger me would have faster stem cell recovery. Our systems work on a balance of all systems working in a homeostasis enironment. When one core system in your body isn’t working properly, then it becomes a domino effect on the other 6 core systems as they have to work harder and can lead to a number of life-threatening and debilitating diseases.


CORE SYSTEM # 1 – Microbiome & Gut Optimization CORE SYSTEM #2 – Immune & Inflammatory Optimization CORE SYSTEM #3 Mitochondria and Energy Optimization CORE SYSTEM #4 – Detoxification Optimization CORE SYSTEM #5 – Optimizing Communication, Hormone Balance & Metabolic Health CORE SYSTEM #6 – Transport Optimization (movement/yoga,Lymphataic massage(body brush)) CORE SYSTEM #7 Structural Optimization (exercise/yoga, rebounding, Supplementation, mind and body healing.
I have spent the last 4 years working on these. Currently just finished the heavy metal detox, working on the gut, I had my hormones checked, and I have an exercsie routine. This is a life time project…I am not 25 anymore...the body needs more as the years pass. Many times because life happens, our health care got put on hold. The quote, “If you don’t take time for wellness then you’ll be forced to take time for your illness.” So True… Pick one and start your quest for a stronger and healthier you!! Have a GREAT month!!
DECEMBER 2025 – “WE KNOW FOOD IS MEDICINE, PERHAPS IT IS THE MOST POWERFUL DRUG ON THE PLANET WITH THE POWER TO CAUSE OR CURE DISEASES.”

”The food we eat can be either the safest and most powerful form of medicine or the slowest form of poison. I know if I am going to get well the food I eat is going to make the bigggest impact. Every month I learn something new. This was my 6th & 7th series of chelation ( hopefully my last) and 3rd remineralization. I feel it has been taxing on my system…taking me longer each series to recover and more tired. Detoxing takes a lot out of your body as it works hard in the elimination process.
This month because of heavy metal detoxing and getting a skin rash on my arms, and neck/upper chest is common, hopefully temporary reaction which indicates my body is effectively purging

toxins through the skin (backup elemination pathway when the liver and kidneys are overwhlemed) this happens when toxins enter the bloodstream faster than they can be removed causing inflammation and skin irritation...the body uses the skin to push out toxins through the pores. Common detox “die off” symptoms when the toxins are released from tissues into the bloodstream too quickly leading to rashes, fatigue/very sleepy, flu-like symptoms/body aches, and poor digestion which last around 4-5 days..this is me everytime.
Detoxification methods like chelation can some times cause heavy metals to move from one tissue to another, temporarily increasing their levels in the skin before they are eliminated.
HOW TO HELP THE BODY DETOX AND RID THE SKIN FROM RASHING
- Drinking a 8oz. glass of of ginger/lemon water in the morning. Ginger is an anti-inflammatory and antioxidant benefits, helping with nausea, digestion, pain relief. Compounds like gingerol; it boosts immunity and brain function while fighting cell damage from free radicals. LEMON WATER Stimulates digestive juices, helping break down food, reducing indigestion. I also use organic cayenne pepper in my ginger water when my stomach feels like my food is not degesting.
- Grate one beet, add 2 tablespoons honey and 2 lemons…cover and store in the refrigerator. Take 2 tablespoons of the juice a day.
- Boil beet peels for 7-8 minutes and drink as a tea.
- Eat nutrient-dense, anti-inflammatory foods like colorful fruits (berries, citrus), leafy greens, nuts, seeds, and whole grains, while drinking plenty of water and herbal teas; these foods provide antioxidants and fiber to support skin healing, reduce inflammation.
- Spirulina…high in protein, iron, and B vitamins. Helps with energy and support. Chlorella – high in chlorophyll and iron, high in detoxifcation in digestion.
- Also I have been taking Milk Thistle to reduce liver inflammation a long with NAC & Glutathione, a powerful antioxidants that support the liver’s detoxificataion processes. I have been doing this for 3 days…so I am hoping within a week and skin rash will be less or gone…especially the itching!!! Sometimes the itching wakes me up at night!! I rub Tea Tree oil with carrier oil and that helps. What helps most is Cortisone 10, but since it is a steroid I have trouble sleeping if I use it at night.\, so I only use it in the morning.



“Food is the biggest “environmental” regulator of our bodies. Helps keep us healthy and stay healthy, as well as over coming disease and illnesses. REMEMBER YOU ARE WHAT YOU EAT.
MORE MOLD…THIS TIME IN THE CARPET!!

So I did a mold test in several of the rooms in our house. I was shocked when I saw these results of our living room and family room…Each carpet is around 15 years old, I vaccum frequently…like every 3 days. Needless to say we will be replacing the carpets with tile. My bedroom has tile, so mold was low. Currently I am running a HEPA filter in the living room during the day on the highest setting; it never shows blue( clean air) always orange and red. At night I take the HEPA filter to bedroom to make sure the air is clean. Most of the time it runs in the blue. When our wall heaters are on the filter turns AMBER or RED.Since I live on the Oregon coast with cool damp temperatures and rain, we will be getting a dehumidifier. I sure hope tiling the floor will make a difference in my energy level!!! I know I would feel better if I lived in Mexico!!!
CHRISTMAS 2025 WAS A NICE AND RELAXED

Besides summer, Christmas is one of my favorite times of the year. I love the spirit of giving…thinking about what special gift to give, give service to others, renewing connection, etc. Gift giving makes the Christmas season a happy time. Since I had just finished my remineralization I was still very tired. I felt physically and emotional exhausted. I did most of my personal shopping on line (thank you Amazon!!) So convienent when your recuperating…just arrives that your door!!! Awesome!! Christmas day I didn’t feel well as I hadn’t slept well the night before, so in the afternoon I took a nap…felt some what better.
The next day I didn’t feel well either and I noticed my tonsil had a white spot..and my throat felt swollen. A few days later I went to Urgent Care test showed negative to strep so they would not give me any medicine. I told them, ” In my 72 years I can not get over an infected tonsil.” Didn’t matter as the new thinking is tonsillitis is a virus…whatever. I was gargling with hot salt water, and steam bathing…didn’ help. If I was not better the next week come back in…which I did. The white infected spot was bigger and I was very tired. So I got the Z-pack…THANK YOU!!! It took several days to recover. I was sick the day after Christmas through New Years but now I am better…Yay!!!!

One of the gifts I received was a grounding mat. Since we live in a cool wet 8 month winter climate(not able to walk on the ground for 20 minutes) I wanted to do everything I could to feel better. Also called a earthing mat,believed to reduce stress, sleep better, and reduce inflammation by connecting you to the Earth’s electrons. Since the earth is rich in free electrons, ground mats provide a pathway to absorb these into the body neutraliing free radicals. Users say the experienceimproved mood, less pain, and faster recovery from exercise, boosts energy, linked to regulataing cortisol (regulates hormones) and calming the autonomic nervous system. Consistency is the key. Starting out slow for 30 minutes a day and you can work up to several hours. I am using the mat 30 minutes a day…each week I will add 15 minutes. Currently, on the nights I use the grounding mat I sleep more sound. If anyone else has used or using a gounding device…sheets, blanket…etc post a comment. I’d love to hear.
DECEMBER FUN!!
LOVE, LOVE, LOVE holding my Great Granddaughter…sooooo sweet! I wish I lived closer and would spend more time giving her loves!!! Such fun experience, takes me back when I had babies…I got to experience holding and taking care of newborns seven times.These times you never forget as they are the highlights of your life. A sweet precious gift from Heaven!



The beach can be beautiful this time of year...the waves are very aggressive with high tides and high surf warnings makes for a beautiful place to regroup, relax and recoup. The lake is a dune lake created by our rain…they are gone in the late spring. It’s all beautiful!! Perfect for Tucker to chase the ball in calm water. I don’t feel comfortable to taking him to the beach with the aggressive waves…he doesn’t always pay attention!



A week before Christmas to get my last remineralization infusion, on the way we drive by this beautiful river . I can never stop to take pictures in the mornings as we have be at my appointment on time. However, this day on our way home the fog was forming again on the river as it does in the morning. So even though I was sick, tired with a headache, and very weak, I stopped at a few spots to take pictures…made my day!!!



With my chelations, remineralizations resulting in fatigue, then my infected tonsil/throat I didn’t have as much energy to do extra activities…just the necessities.Top of my list was decorating the house and wrapping gifts I ordered online. I tell myself “Next year I will be stronger!!”. We did drive around on several occassions and looked at houses decorated with Christmas lights…Very Cool! I was hopping to go to the lights at Shore Acres (the biggest light display on on the northwest coast) but never had the energy. Grateful many years ago we purchased 12 lighted Christmas house decorations…so I can have my own Christmas light show in my own home…helps with the Christmas spirit!



When you have an illness which keeps you mostly house bound you have to be creative making life in the house happy, comfortable, and festive. Always with the mindset of resilience bouncing back from disappointments, failures, rather then being dreailed by them. Keep a mindset of passion and preseverance…an internal drive and commitment to the long-term goal of heatlh with a tireless effort to achieve it. My passion!!
In my experience having an open mind, constantly aware of new and different directions, new medical findings in foods, herbs, teas, supplements, cell building supplements, keeping your house air clean-mold free…NEVER, NEVER STOP LEARNING, LISTENING, DIGGING, READING, ASKING QUESTIONS, TALKING TO OTHERS…THERE’S ALWAYS SOMETHING NEW YOU CAN TRY. (I am trying something new in a couple of weeks) There is not one cure-all…it’s a combination of many. Be determined with a passion for health for the long term goals and a determination to overcome challeges and setbacks without giving up! It’s been an 8 year journey…and still working on it. Our body is constantly in a healing process while we sleep and during our waking hours. We have to make sure the healing repairing process is 100 percent…otherwise we are subject to disease and tired organs. Remember…you are what you eat…food is medicine with the power to cure disease or cause it.
HAVE A GREAT HAPPY HEALTHY NEW YEAR!!

NOVEMBER 2025 – DOESN’T MATTER HOW OR WHERE YOU START, WHERE YOU’VE BEEN, IT MATTERS WHERE YOU END.

In my experience with my daily stuggle with fatigue…this quote rings true to the last seven plus years of my health/energy struggle. Dealing with health issues is a part of most peoples lives, expecially after 50. Some of us abused our bodies in some way…through poor diet, too many sweets (me), not enough sleep, (me) over exercising, (maybe me) but I’d probably do it all over again…LOL. Using more nutrients, energy, vitamins, than we were replacing resulting in tearing down of our systems until we begin to feel sick…then the fight is on to heal the body, find where our system crashed and why, then to work to return our body back to a homeostasis balance – a process which the human body maintains a stable and balanced internal environment despite constant changes in the external world. Working on it…..

In the month of November I had two more chelation infusions, and a reminerlization infusion…to give back to the body minerals the chelaters flushed out which gave me a migraine pressure headache (laid on the back seat of the truck on the way home) for two days sleeping with a hot pad on my forehead at night. I have one more reminerlization December 16th hoping I don’t get a migraine!! They also cause fatigue for several days.
LEAKY GUT
My doctor is focusing on lowering and eliminating the heavy metals, mycotoxins, and also heal the “gut” THE GUT COMPRISES 80% OF OUR IMMUNE SYSTEM. If your gut is inflamed or eat foods that you are senititive to it causes an immune reation and your defense system begins to attack the food particles inside your intestines causing inflammation and this sends a signal through your vagus nerve to your brain something is wrong . Your brain sends signals that are enterpreted as increased anxiety, nervousness, depression, fatigue, brain fog, or some other type of deeper imbalance. Leaking gut is now correlated with over 90% of all auto-immune diseases. Also, causes allergies, chronic fatigue, multiple chemical sensitivity, poor digestion…this is all me.


To balance microbiome eat a plant-rich diet with plenty of fiber, prebiotic -garlic, onions, oats, and fermented food (yogurt, kimchi for probiotics) cutting out sugars (the hardest part), processed foods, unhealthy fats; then stay hydrated, get good sleep, & exercise. Not hard but I have to be conscious all the time eating foods that will make the gut happy. In my link on my homepage Simple Happy Gut Health Foods to Make I have listed several healthy gut foods you can make and buy. Since creating that post I have learned about other useful gut foods, supplements and powders.



Pure whole leaf aloe drink is contains enzymes that can help breakdown of sugars and fats and keeps you digestive system running smoothy. I drink it before I go to bed
.Brew Dr. Kombucha is an Organic, raw and probiotic. This is my pop.
Slippery Elm Bark workings as a demulcent, forming a soothing protective barrier along the entire gastronintestinal (GI) tract. Leaky gut Revive
Leaky Gut Revive calms the gut providing nutrients like L-glutamine and aloe, marshmallow root, to repair the gut lining, smooth inflammation, strengthen the gut barrier and supports a healthy microbiome to relieve digestive issues, bloating, gas, food sensitivities, and fatigue all linked to a compromised gut.
MEGA igG2000 is dairy free bovine serumderived supplement providing Immunoglobulin G to support a healthy gut barrier, digestion, and the mucosal immune system by binding to pathogens and toxins. Taken at night before you sleep.
Bergerine helps balance gut bacteria, reduces inflammation, strengthens the gut lining, and figthts harmful microbes. It acts as a selective antimicrobial, encouraging benefical bacteria like Lactobacillus and Bifidobacterium while slowing down bad bacteria.
Healing the gut takes anywhere from several months for sigificant improvement, however, in some cases six months to a year. I’ve been working on this for 3 months. I feel the gut is getting better, but still have lots of food sensitivities and my stomach still hurts off and on. So I still have a way to go. I take 1/2 dose of the MAGA IGg2000. I alternatae the powders as it is too strong for me as well. It’s a process…I’ll get there.
BLACK MOLD – INVISIBLE TOXIC SPORES!!!
For many years off and on when sleeping in my bedroom I would wake up exhausted so I would sleep in the living room until I could find the reason for my fatigue. I ended up taking out all my clothes and everything else except for two bed stands. Also vacuuming often including under the bed and mattress when changing sheets weekly. This all helped. However it was always a constant battle. Ten years ago when Steve was repairing a water leak on the outside of our bedroom window found that water was also coming into the bedroom and down the inside of the sheet rock, onto the subfloor under the carpet. I hadn’t sleep in my room for about 5 years. So all the floor was replaced, sheet rock, baseboard trim…everything down to the 2x4s. Yes!!! Back into the bedroom. Things went well for a while until the last 4 years.Always making adjustments… using white vinegar and baking soda to wash my bedding…so no smell. Over Thanksgiving this year I tried to sleep in the room again. However, by a week and a half I was sick exchausted. So back to the living room again.


Steve and I had both notice what looked like dirt or paint wearing thin especially on the west side of the house.Upon further inspection I took a towel to see if it needed paint or was dirt. To my surprise it was black mold growing on the the hardie plank of our house…the house was power washed in June. Not only was it on the west/south side of the house, but on the west sides of my bedroom(right around and under my window which I leaved cracked at night) and covered a couple other outside walls as well. Now I feel as though I am surrounded by black mold spores! This is the first year we’ve had a problem with black mold outside on the siding.So no wonder I was getting sick sleeping with the window open and the mold spores were coming into the bedroom.
Black mold (Stachybotrys chartarum) exposure often cause allergy-like symptoms…sneezing, runny nose, sinus infections, coughing, wheeezing, asthma,eye irrtation(itchy eyes) headaches, fatigue, skin rashes, etc…which I have all. Black mold is a mycotoxin these toxic compounds are released into the air through spores and fragments, and they cause a variety of health issures, such as respiratory problems, allergies and asthma-like symptoms. Long term exposure can lead to neurological issues.

So we will be power washing the house with purex and white vinegar scrubing with a broom, then I will use an ozone generator creates ozone (O3)to oxidize and break down contaminants like odors, smoke, bacteria, and mold by releasing a reactive oxygen-based gas. Ozone generators use electric current or UV light to split oxygen molecules (O3)into single oxygen atoms in the room. Runs for 2 hours, close the door and leave the house for 12 hours. KILLS THE MOLD! ) to oxidize and break down contaminants like odors, smoke, bacteria, and mold by releasing a reactive oxygen-based gas. This all will take some time, especially with the Holidays coming, so I am hoping sometime in January I will be able to SLEEP IN MY BEDROOM AGAIN!!!
NOVEMBER – FAMILY TIME- THANKSGIVING WEEK
FAMILIES ARE LIKE BRANCES, WE GROW IN DIFFERENT DIRECTIONS, YET OUR ROOTS REMAIN AS ONE.
Even though every month has it’s difficult times there are always positives…time with family is the best – making forever memories. LOVE looking back on pictures and remember the fun times.






FUN to go to the beach with family who enjoy the beach as much as I do! Always a different look, always beautiful, always peaceful(when there’s no wind) alway love the sound of the surf. My granddaughter, Jaelee, walked out thigh deep to get some really awesome pictures…I could never do that even in the summer!


Always fun to have family on the holidays…everyone was so helpful during the Thanksgiving week…Always lots to do but I had so much help. Our son, Greg and his family came for a week. Gregs wife Darci brought 5 days of home premade dinners… home made pizza, it was delicious and Taco night!!! Home made chili with bread and rolls…yum! So nice not to have to worry about cooking dinners!!! Greg comes to elk hunt, Steve and Greg, hunted everyday and sometimes they took a couple of grandkids for help. Good Times! The best part we got an elk this year on Thanksgiving day!!!




The week was busy with preparing for Thanksgiving, pies, turkey, stuffing, boiling eggs, precutting for the veggietray, Jaelee & I worked on a craft, looked easy online, however, when we worked on it not so easy…so this year no completed crafts…I promise to do better next year. Hoping to feel better and make the craft first! Friday we all went shopping in Coos Bay. Greg needed a pot to cook the elk head as he makes a European Mount with the head and horns. Darci & Jaelee wanted to go shopping and of course I am always up for shopping!!!We went to couple clothing boutiques and we all came home with treasures!!! One of my favorite things to do!!Sunday of Thanksgiving weekend Steve & I went for a drive I was looking for mountain fog pictures with the sun coming through but there was no sun and no low fog. However, we did drive by one of our local waterfalls I haven’t seen for a while…so pretty!!!



Mark Hyman, M.D. author of New York Times Bestseller, ‘Young Forever’ stated, “The best gift doesn’t come in a box or sit under the tree…it’s your HEALTH. Invest in yourself by choosing nourishing foods, staying active, and prioritizing rest and connection. After All the greatest gift you can give your loved ones is a healthier, happier version of you.”
Even though it is winter and the tempertures are wet and cool/cold put a coat on and take a walk, bounce on a mini tramp (I do every morning outside, rain or shine), do something active! Eat healthy clean foods (nothing processed), drink plenty of water and other healthy drinks (low in sugar and artificial coloring or flavoring), plenty of veggies, protein, fresh fruit(especially blueberries, kiwi, strawberries, and a banana a day. Be the best version of you! See how you feel after a month, two months, six months, a year…. This is my goal everyday, every week, every month. I will get stronger!! When you feel good, LIFE IS FUN!!!
October 2025 – Courage doesn’t always roar. Sometimes courage is the quiet voice at the end of the day saying, “I will work on this tomorrow.”


This has been my story for the last seven years…always hoping tomorrow will be a better day. October has been a long struggle as well. I approached each day with thinking maybe I will feel better today. Hoping I would feel well enough to go tubing (still some days were warm enough)or riding on the dunes as I had been too tired all summer. Always watching I’m eating, drinking, supplements I’m taking, soaps I’m using, food I’m eating…trying to find something that might also add to my chemical load that is contributing to my exhausted state. In late October I decided to stop drinking from my Berkey water filter and changed to the plastic water bottles from the store. The next day I was much better. I don’t have any answers why the water filter is causing fatigue…maybe the carbon filters? I had just cleaned it a week ago. Now I am drinking the reverse osmosis water (suggested by my doctor) from the machine at our local grocery store. Living every day searching change to make a change, never knowing if it will help or make me feel worse, at the end of my day as I lay down to sleep,I always think “I wll work on this tomorrow.” Personally, this chelation infusion has resulted in extreme exhaustion.I truly hope come Jan/Feb the body/cells has time to heal enough to produce energy.
Remineralization IV – Isn’t for the faint of heart!

After every chelation series 2-3 IV sessions, I have a remineralization IV, takes about 2 hours. For 15 minutes after the mineral infusion I felt a little off and detached. The next day I had more energy…NICE!! Since minerals are critical/essential our blood and organs performing many functions from regulating fluid balance and supporting the immune system, in the process of heavy metal chelation, many minerals are flushed out as well. I will have two more remineralization infusions. In all I will have three remineralization IVs. The one I had in October, one after the series of IVs in November and one after the series of IVs in December. Then cross your fingers I feel better come January!!!!
So it is crucial to replace essential minerals in our system, which include regulating nerve and muscle function, maintaining heart rhythm, energy production, DNA synthesis and protein synthesis. and supporting bone health.
Unfortunately two days after my remineralization infusion in October I came down with strep:(:(:( and didn’t get to feel the energy I was suppose to feel. It took a week and a half to feel well enough to leave the house. Again thinking “I’ll work on this tomorrow,” in hopes of feeling stronger the next day. I have another remineralization in a week…so waiting to feel the energy!!! I hope so Thanksgiving is the next week after!
MY Menu – All organic -Very simple right now


Eating good has been a challenge…not feeling well, meals needed to be simple. All organic…I don’t want to add more chemicals in my system when I trying to get rid as much as I can. Breakfast -cooked millet or Quinoa, banana, and flaxseed. Flaxseed is good for heart health, digestive health, and may help reduce the risk of certain cancers. It is rich in omega-3 fatty acids, lignans, and fiber, which can improve cardiovascular health by lowering blood pressure and cholesterol, aid digestion.
lunch – is hard..sometimes leftover elk steaks or gluten free breads and english muffins (that I make) with tigernut butter, nuts, blueberry muffins, or home made split pea soup with ham.

Dinner – I still eat small lettece salads, a lot of elk meat in my bone broth with noodles, black beans, and garbonzo beans. Stir fry elk steak with rice or noodles, carrots, celery and chard is good! I love elk steak with cooked yams. YUM! For fruit I snack on grapes, apples, blueberries…whatever fruit is in season. My doctor only wants me to eat 3/4 cup of fruit a day for gut reasons. Currently, I don’t have energy to be too fancy and simple is better so I don’t eat something my system doesn’t like…then I will pay later…stomach doesn’t digest well…Hoping this will all get better in time. I drink a lot of ginger water to help with digestion. Again.. I think in the evening when I don’t feel well, “I’ll work on this tomorrow” and hope I can feel better!”
Never never give up on your health…If you’re not feeling well, keep looking,reading, talk to people, keep trying, you will find the right person!!
Positives -“Success in life is not for those who run fast, but for those who keep running, running, and running…..”
Fun Times in October – Create and Make Positive Moments

We had a very exciting addition to our family – a great granddaughter was born!! The sweetest little baby girl!!! I simply love to hold her. They live around two hours from us and so far we have been able to visit twice. She is our third great grandchild! Sweet, sweet, sweet!! Family is everything! I wish we could see our other great-grandchildren more. Thankful for technology and social media where we can see vidoes and pictures often! Always makes me smile…very proud of them. It is exciting to watch them grow!
As I have posted before the beach is one of my favorite places to spend time…it is always beautiful, always looks different…the water, the sun the clouds, sand, tides. etc. The sound of the waves are so relaxing.



My favorite places to take pictures are the beach, sunsets, Coastal mountain range, and fall…love the colors!



Fall pictures of Loon Lake…my summer fun place to be!!! Taking pictures is one of my hobbies. Capturing a moment in time you’ll be able to remember forever. While struggling with my health, photography makes me happy. Taking pictures of nature brings peace to my soul.



I had the opportunity to watch a granddaughter play volleyball her senior year. It has been such a fun experience watching her develop her skills to become a talented and a gifted player. It takes hours of time and lots of hard work. Go Mackenzie!



Living on the west coast has many advantages! Even though the weather is cool, it has many beautiful places along the coast. Shore Acres is on of these beautiful places year around. Whales have been spotted here many times. Pictured below are the waves created by the king tides with wind and storms. In the winter the gardens have a Christmas light show from Thanksgiving to New Years. In the spring and summer are beautiful flower/plant gardens. Lots of history of how Shore Acres came to be.




For my Mental Health – Even though I am not able to do the activities I use to do, I has always been important to me to get out and appreciate nature. Do I feel well when I am out…No. For now, I have to pace myself, only do so much walking before I have to sit down or be done. There have been times when I have went back to the truck..eat and lay down…sometimes sleep if I have to. The pictures are my Happy Places, which always gives me a mental lift. Taking pictures gives me purpose, I love to edit them. My mental health is just as important as my physical. For my mental health I need to exercise daily, get outside once each day…even in the rain, walk, 6-7 hours of sleep, connect with family members , and spend time in nature. This helps me deal with my health. I still choose what I am going to do each day… I still have control!!!!
September 2025 – Life doesn’t get easier or more forgiving; we get stronger and more resilient”
September was a tough month…since it is the last month of summer, and always wanting to feel well enough for outdoor activities before the cool rainy weather, everyday I was hoping to feel well enough to go tubing at the Lake, ride my bike, walk on the many trails here on the coast to the beach…etc. I watched the weather everyday thinking, “Ok, if I feel good on Thursday (or any day of the week) “we will will go tubing.” However each week passed with me not feeling strong enough. All I had energy to do was lay on my deck in sun



and sleep. I did this every sunny day. I am very grateful I was able to go to our place by the river a couple times and I would lay in the sun and float. I am an outdoor person…if the sun is out so am I. However, many times too tired to go to the store to grocery shop or I would go and sit in the truck while my husband, Steve, went in and did the shopping. Each summer month brought a new level of tiredness. In the last week in September, stopped sleeping in our bedroom…and this helped some. This has been an on and off going problem. I can’t figure out what would be in there…not much more than a bed, would make me so exhaustly tired and nausated with brain fog. I continued with the extreme fatigue, but mentally felt more clear and my digestion was better. However, by the end of September, on most days, I was too tired to just walk around our local park. On September 24th was my first chelation infusion!!! Finally!!!!
This is my first heavy metal & mycotoxin chelation infusion


I was so tired on the morning of the chelation I laid down in the back seat of the truck 1 1/2 hours to the doctors office. The infusions take around 2 hours. Afterwards I felt detached and hard to process information. Then for the next 4-5 days I am exhausted and not able to do much physically. I have chelation for 3 weeks in a row. Then an IV of remineralization as the chelation rids the good and the bad. I then have a week off, then 3 more weeks of chelation, than another remineralization. I should be done November 19th. So it is a process. I am on a supplement schedule to help detox out the mercury, lead, tin, and all the mycotoxins in the system as well. Also vitamin therapy to replace nutrients. Then in January I will retest again to see if my numbers are down where they should be. Fingers Crossed they are!!!!!
What does Mercury & Lead do to the cells – Leads to cell death
Mercury and lead damage cells by generating reactive oxygen and causing oxidative stress, binding to and inhibiting crucial enzymes and proteins, disruptin cellular functions like calcium signaling and leading to mitochonddrial dysfuction, DNA damage, and leads to cell death. Also leads to damage organs, such as the brain, heart, and kidneys. Not Good!
The consequences of cell damage causes Neurological disorders– because of damage to the nerve and brain tissues. Also causes cardiovascular disease from damage to heart cells and blood vessels. Kidney damage and chronic kidney disease is caused from lead and mercury in the body. Lastly, Cancer as heavy metals promote the cellular conditions conducive to tumor growth. SCARY to think how many years I have had an overload of heavy metals in my system…at least 10 years.

The doctor told me in all her years of practice I have the highest mercury and lead levels she’s seen. So it’s going to take a while after the chelation for my system to heal and function properly to have sustained energy. She also suggested I get mitochondria injections (afer chelation therapy). Since mitochondria is the powerhouse of our cells, responsible for generating ATP (the main energy currency) and other vital functions injections can lead to increased energy and improved metabolic functions. We have dozens of quadrillions to 100 trillion mitochondria organelles within our cells. The heart muscle cells contain the most mitochondria estimated up to 5,000 per cell because of its high energy function.
How to keep the mitchondria Healthy – Excersise & Diet
- Regular physical activity…walking, running, biking, jumping or bouncing on a rebounder, any arobic excersise. Movement, Movement, Movement especially outdoors!
- Healthy fresh foods…fruits, vegetables, nuts, fish, all include your omeg-3s, B vitamins. Also include lean meat and healthy fats.
- Antioxidants: Foods high in antioxidants – blueberries, dark chocolate, and kale all protect mitochondria from oxidataive stress.
Also, will protect against cellular damage. to act as antioxidants to combat oxidative stress and free radical damage. which harms mitochondria and causes aging. So I am going to pursue this option as well.
When I first got sick seven years ago and had labs done, my mitochondria numbers were down. Now they are back up where they should be, however, still working on the other issues...heavy metals and mycotoxins.
If you have unexplained fatigue and it progressively becomes any level of debilitating fatigue find a holistic doctor who will test you for heavy metals and mycotoxins. They will destroy your health. I tried many directions for 7 years… helped some, but NEVER got my energy back. I learned a lot about clean eating and nutrition, but unless you clean out your cells they won’t function properly no matter what you try. I tried oral deotoxing (detoxing supplements) for 2 years…helped some…but never lasted. After a few months I was sick again…back where I started. Keep looking until you find your answers!!!
Fall garden – When the big maple leaves start to drop – fall is in the air – noOOOOOOOO!!!!!!!!!!!! Not a fan of summer coming to a close…




“to plant a garden is to believe in tomorrow.” Audrey Hepburn
I love the colors of fall-the turn of the leaves, pumpkins, crispness of the mornings, but I don’t like the cold and the rain, rain , and more rain. Many plants are at the end of their growing cycle…tomatoes, pumpkins, strawberries, cucumbers, potatoes, blueberries, snap peas, etc. Time to clean up the garden of dead plants and prepare for winter by covering the strawberry plants. I grow a winter garden as well of lettece, cilantro, and carrots. Come November I will cover them in clear tubs. Sage, thyme, and oregeno grow year around … nice! Eating FRESH tastes so much better and it healthier for you! Studies say gardening is a powerful stress reliever, and can lower stress hormone levels which increases calmness and relatation. I enjoy working in the garden…so fresh looking, so green, and fun to watch the vegetables grow!!


September Positives
Labor Day Weekend with family. My best memories and fun times are with family. My son and his two boys came to visit for the weekend…a traditional crabbing trip. Usually takes a few hours out in the bay to get a limit. The weather was warm and sunny which always makes it more enjoyable! It’s catching, cleaning and cooking…it’s a process. Starting at 12:00 noon to around 5:00pm ready to eat. YUM!!!








September Sunsets – There were many colorful sunsets in September; however, I was so tired in the evening I was only able to capture one. Sunsets are one of my favorite times at the beach…the Golden Hour. The beach becomes alive with changing colors as the sun set over the horizon. Always different, always beautiful!!



Watching Granddaughters play volleyball – Watching and following our own kids, grandkids, then great-grandkids play footall, basketball, baseball, track, softball, volleyball, and soccer has been a major part of our life. Watching the kids start in the elementry grades, develop their skills into high school competitors. Not only rewarding for us to watch the develpment, but for these young kids mature into young adults with resilience, tenacity, determination, team leaders preparing them for adulthood is rewarding. Sports, with inspiring coaches, has more to offer then just the play, so much more to be learned. In September we watched our granddaughters play with passion. Always a fun time!!! Both girls teams won !!!






Love my beach days….a place that is always beautiful and relaxing…I love sit on a log and close my eyes and listen to the seagulls and the surf. It is my HAPPY PLACE!!



August 2025 – If the Earth don’t make it – don’t take it!

Perfect Advice!! Thinking about what I ate today from the earth, bread with Tigernut butter (both plant grown), walnuts, pecans, and brazil nuts with figs, plums…Dinner was lettece salad with blueberries, and chopped apple, elk steak and organic long grain brown rice. Think about all the foods earth grown, you could easily survive. The Indians, pioneers, for many years survived on only the foods they grew themselves and were much healthier than us. As a country we would have less diesease if we only shopped fresh organic produce, fruits, grains, and fresh meat, and fish. Absolutly NO PROCESSED foods. NOTHING IN A BOX. Growing up in the 50s & 60s this was 90% our diet. We occasional had cookies, and cake made from scratch…there were no box mixes!!

Herbs from the earth

I rely on many herbs for health – digestion, wellness, healing, detoxing, moisturizing...there is an herb for every illness. Listed below are some the common herbs I use…some daily.


Chamamile, Passion flower, Skull cap tea– Helps with sleep. Green Tea – Heavy metal detox – currently using this for detoxing heavy metals.
Thyme – Antibaterial, antifungal, antimicrobial, antioxidant, antiviral, antiseptic..I use it for sinus infections…cured me after 10 long years of sinus infections and headaches.
Sage – antioxidant and anti-flammataory, supports brain health, digestive health, antimicrobial , used to support bone health. I use it for digestion, bone health, and anti-inflammatory.

Peppermint – Antibacterial, anticarcinogenic, anit-inflammatory, antiseptic, antiviral. I use it for digestion, add a drop on my toothbrush to help with cavities, headaches, and also use it for sinusitis…steam baths everytime I get a cold.
Oregano – Antibacterial, antifungal, antiparasitic, antiseptic to the respiratory system, antiviral and immune stimulant. I used oregano to cure my sinus infections, but has many other uses…canker sores, candida, staph infections, warts,…etc.
Rosemary – Analgesic, antibacterial, anticancer, anticatarrhal (clears out excess, thick mucus from the sinuses, ears, nose, and throat), antifungal, anti-infectious, anti-inflammatory, antioxidant, and expectorant. I use it as a mouth rinse…cut down on cavities, use on my skin on any sun spots since it’s anticancer, and promotes hair growth, I put it in my conditioners.


Echinacha – is antivitral, antibacterial, anti-inflammatory and antioxidant properties with immune support in fighting infections. I have used it for years with tonsilities, sinus infections, swollen glands, sore throats..etc. It is an amazing herb.
Frankincense – anticancer, antidepressant, anti-infectious, anti-inflammatory, antitumor, immune stimulant. used for Alzheimers, arthritis, brain injury, brain aging, coma, concussions, liver cirrhosis, Mental fatigue, parkinson’s disease, tumors, ulcers, virus of nerves, Lou Gehrig’s disease and wrinkles…etc. Since I am sensitive to smells, I rub this on the bottoms of my feet. I use it as a immune stimulant, helps with fatigue, and over all health. I wish I knew about frankincense when my mom had Alzheimers.
Cloves – Antibacterial, analgesic, antifungal, anti-infectious, anti-inflammatory, antiparasitic, strong antiseptic,antitumor, antiviral, disinfectant, antioxidant and immune stimulant. I use it for tooth pain, before and after the dentist, liver cleansing, and cold sores. Also it is good for memory, muscle aches and pains, candida, cataracts, metabaolism balance, osteoporoisis (might need to try this), and rheumataoid Arthritris.

Lastly, SourSop – Anti-inflammatory, can help control blood sugar, has antibacterial properties, can lower blood pressure, and kill cancer cells it is concentrated in acetogenins – which has evidence suggesting strong anticancer effects. It also contains alkaloids, and flavonoids, which have anticancer and antioxidant properties. I use this oil on skin that has been exposed to years and years of sun in hopes of not developing skin cancer. I am all about prevention!!
Bone density results – recommended by my functional medicine doctor
Chart below. Anything greater on the negative spectrum than -2.5 is considered bone loss. At risk in time for fracture. So my spine is -3.4, my left hip is -2.8, my left femoral is a -3.1, right femoral is a -2.8. Forearm should be at 25%…not 33%. So some bone loss…

On a positive note I am still 5’5″ !! Recommendations Vitamin K 2, Vitamin D (especially from the sun) which I do, weight lifting (which I do) and a Calcium supplement. Eat more figs, dates, chic peas, yogurt (coconut yogurt) all good sources of calcium. I have food sensitivities to all milk products…so have to get my calcium else where. Something else to work on…
I would recommend anyone over the age of 60-65 to get a bone density test…just so you have a starting point. Then you will know if you should be proactive in keeping bone strength. It was suggested I test again in two years.

the month of August was a tough month…but I could also include june & July as well…Most of summer…
I always felt so exhausted...is it the heavy metals in my system, is it something I am eating, drinking, smelling, using and absorbing? We had family here in June…sometimes I would feel sick tired…but just kept going. I wouldn’t be denied not wanting to miss out.


It’s always a guessing game…so I switch shampoos/conditioners, water, rewashed my bed sheets in vinegar and baking soda (absolutely no smell), drink straight creek water to see if it is my water filter, changed the filter in the shower. Nothing seemed to help. I felt every couple weeks I was getting weaker and weaker. Our summer outing, once a week if weather allowed, was to sit by the rivers edge and sit in the sun and I would swim a little and float. However, the next day I was always tired from it. I was too tired to tube, or even try to ride my bike, go to concerts, Semi pro baseball, or buy tickets to our favorite college football team. Also too tired to walk our grandson’s dog, Tucker. I felt like sleeping all the time. However, sometimes in the evening I would better, especially after sitting in the hot tub. I have to change something I am doing, eating, or nothing will change…it just won’t go away on its own.
Changes: Unplugged the WIFI to the Television on the bedroom, took down two color canvas pictures, and switiced up the mattress and vaccumed it. So we will see…fingers crossed!! I have to keep trying!!!
The Attitude of Graditude….Positive anything is better than negative nothing..LOL
I grew up on this beautiful river and in the summers swam every warm day. The shallow water is warmed by the sun…bath water warm. I don’t live by the river now but it is only thirty minutes away. Even though I don’t feel strong or well this was my Happy Place this summer… even if all I could do was sit. Usually after a while I would blow up my floatie and float down some small rapids and lay on the water. It was a great get-a-way!! Takes my mind off my tiredness.



August wherre I live were a lot of foggy mornings and evenings…hard to guess when a great sunset might occur…but of course, I found a few…this is also my “Happy Place.” I like to sit on the beach after the sun has set and just listen to the surf and watch the “golden hour” turns to twilight/dusk…a stillness settles over the beach.



Another event on the dunes here in August is the UTV Takeover. Riders from all over, even states away, come to our dunes with many types of All Terrain Vehicles… ATVs...of all different sizes, horse power, different types of side by sides. They ride all day long into the night. One of the parkings lots is full of ventors. I went down there with my grandson and we watched and walked around all the vendors. Busy Busy place!! Fun!!






Vince Lombardi said, ” “WINNERS NEVER QUIT AND QUITTERS NEVER WIN.” True statement!
Before I got sick I felt fearless…whatever idea I had whether it was having a large family, how far I could run, races I ran in, going back to school, coaching, teaching …when I had an idea/goal with a plan I could do it. I felt determined and resillent to make it happen, to do whatever it takes, if I fell short, regroup and go again. I thought many times, “If I feel good I can accomplish anything.” This has continued to be my challenge the last seven years to continue to be fearless, determined and resillent, even when I am not feeling well. Always looking, reading, listening to how others healed themselves, the foods they ate, supplements they took, what excersise they did, and the types of health professionals they sought. This has kept me going…I keep trying to find the answers…is the only way to get the answers. I WANT MY LIFE BACK! Yes I will tube weather permitting before winter, and I will ride the dunes. I will walk to the park again with Tucker, I will jog again. I will travel to see family without worrying if I will feel well enough. I WILL ALWAYS HAVE HOPE for better stronger days!
July 2025 – Take care of your body – It’s the only place you have to live.


I wish I would have been more informed about nutrition with what is healthy and what causes disfunction/illness/disease as “you are what you eat.” Most how damaging it is to your cells. Our cells have to power to heal once you allow it to return ot a state of equilibrium. It is the imbalance of one of our many systems that causes us to struggle with disease. We don’t know where our weakest link is until we start having symptoms. Finding the imbalance is the hard part!! I have spent the last seven years trying to find the reason(s) for my extreme fatigue.
It has been with me for decades with chemical & foods allergies which caused a unmanageable level of tiredness …then the crash where I laid on the couch for months/years. I read everything I could on eating, strengthening the immune system, rebuild the adrenals, chemicals, toxins, food sensitivities, etc. to try to become a healthier me. The books to the right I read from the top to bottom some books twice. The book “The Rain Barrel Effect” by Steven Cabral, is a must on recognizing, reducing, eliminating toxins with a follow up consulation. I did my heavy metal/mycotoxins and minerals test through them.
I haven’t finished the “Glucose Revolution” yet…very interesting…explains why so many people are prediabetic and why so many are diabetic. “You can’t unknow what you know.” Gives you a absolutely new perspective on life sytles, what is healthy food, when to eat your food, and how your system is reacting. recipes, etc.
Sadly since I wasn’t able to continue with the chelation infusions (doctor having shoulder surgry)Istill have 3 more infusions.I am still am very tired from morning until late evening. I feel tired, sluggiest, and sleepy. I have a little relief after I sit in the hot tub around dark. I thought juicing vegetable drinks…very healthy, might help my sytem have more energy. I love veggie drinks…5-6 elery talks, 1 carrot, 1/2 lemon, a chunk of ginger and


a slice of a rutabaga, 1/2 cucumber, 4 stalks of asparagus, slice of raw beet, & 4-5 chunks of pinapple or( blue berries, black berries, strawberries, etc)…makes about a 12 oz drink. I also add barley grass juice powder ( binds with heavy metals) Best to drink in the morning before you eat. I will do my next chelation infusion the end of September. My thought is … if I can rid my system of some heavy metals maybe my reaction won’t be as bad as last time. Also to help detox heavy metals is green tea, cilantro, and curry. So I eat these most everyday. Barley grass is high in magnesium, minerals, vitamins and antioxidants.

Benefits of Juicing – Drink within 5-10 minutes of juicing for getting the most vitamins from your veggies.
Nutrient Boost – provides a concentrated source of vitamins, minerals, and antioxidants.
Improved Digestion -especially with the lemon and ginger, helps absorb nutrients by breaking down the fiber in fruits and vegetables, reducing bloating and indigesting. ( I have a lot of trouble with digestion) I don’t have my gallbladder.
Natural Energy – The vitamins and minerals in fresh juice can provide a sustained energy (which I need) lift without the jitters or crashes…like sugar drinks or caffeine.
Immune System Support – Juices can help strengthen the immune system becuase of their high concentration of vitamins and antioxidants. If my immune system was stronger I wouldn’t have so many allergies!
Potential Detoxification – Juices can help with detoxification by providing nutrients that aid the body’s natural cleansing processes…which is one of my reasons!
On The Positive Side
How’s your garden growing…
Growing a garden has so many benefits. I have grown a garden for many years..even when our children were small. Yes, gardens are a lot of work, yes, gardens take time, yes, you have to fight the emeny (bugs). Yes, the veggies taste so much better, yes, you know they are organic and chemical free, yes, they taste fresh and have more flavor, yes, they are fresh…so more vitamins!



I started eating organic food many years ago when I became chemically sensitive and develped many food allergies. After many trial and error of what foods grown on the cool, wet Oregon coast and the techniques of growing in the cool climate I have had more success in these last four years using garden beds…less weeds, a more controlled growth. This year I have tomatoes, carrots, blueberries, strawberries, cucumber, and squash. However, every year certain plants, for whatever reason, will go crazy. This year it is my snap peas, pumpkins (they are taking over the garden), raspberries, cilantro, oregano, sage, and lettece. I love going into the garden and eating fresh strawberries, carrots, snap peas, blue beries…it’s a treat! Last winter I grew lettece and carrots under clear plastic tubs…worked great!!!
YOU ARE WHAT YOU EAT…so who were you today??? I was veggie juice, elk steak, watermelon, nuts, AIP banana bread, snap peas, large salad and elk steak slices for dinner.
Sunets are still on my favorites to photgraph…I look every night towards the west and I HATE it when I am too tired to go!!!! I just love going to the beach and listening to the waves, watching the birds, and feeling the sand between my toes. It’s always beautiful and peaceful there!!!



I am changed by my ability/energy to do the things I want to, but I refuse to let it define me. I want to have the energy to enjoy family and not have to pace myself worrying I am getting too tired and crash. I will never let go of my goals to run again, run in a race, ride my bike, drive a vehicle… to Coos Bay/ Florence, Eugene, drive on trips, travel to see family. I think about it everyday… ONE DAY I WILL!!
June 2025 – When the going gets tough…the tough get going (my dad’s motto)


This quote is my life everyday…some days/months more than others, but June was such a month. With some anxiety (my system is very sensitive) on June 18th at 9:00 in the morning I got my 1st of 3 chelation infusions for the heavy metals and mycotoxions. It was only 1 1/2 hours and for 6 hours after you keep your urine samples to send back to the lab to test what and how much you detoxed. In the afternoon I felt sleepy but nothing alarming; however at 1:00 in the morning I woke up to burning, stinging skin all over my body, my head had so much pressure, and my tinnitus was very loud. It was awful…I didn’t know what to do. I drank a big glass of water with 2 activated charcol capsules and two tylenol for pressure in my head. That helped for 2 hours…I slept some. Again at 3:00 the stinging and burning was back, so again I took another glass of water with 2 more activated charcol capsules. I woke up one more time and repeated taking the activated charcol. When I felt good enough to shower at 9:00am most of the burn/stinging was gone and I slept most of the day. The next day I was exhausted and for the next week and a half I still felt the effects of the chelation. When I spoke to the doctor the next day she told me, “In all her years of practice she has never had that reaction from chelation.” I don’t know if it was an allergy reaction to one of the ingredients in the chelation infusion…??? So feeling very nervous for having another… after 4 weeks now I don’t feel the effects, but my ears still ring louder; however, I don’t feel any more energy. I am scheduled to have another appointment with the doctor on July 21st to discuss the results from the chelation and what my next steps will be. This was such a crazy scary experience!!
Chelation Test Results
As you can see there were some toxic metals in my system, Antiony, Barium, Cadmium, lead, tin, and mercury… which cause fatigue and other nasty symptoms. I have been eating a lot of cilantro, barley grass juice powder, curry, thyme, chlorella, green tea, all of which pull the metals from your system. Idid this 4 years ago…I’ve come to the conclusion for the rest of my life I will always have at least 3 of these foods a day.

I’m continuing to eat AIP, low inflamatory foods…salads, vegetable stir fry, bone broth stew, gluten free breads, some nuts, dates, yogart and some fruit. Every so often I do cheat and little….LOL.
Always want to end On a positive note…

The first week in June family was coming for a week …always worried if I can keep up and be a part of the activities. We drove up the coast to meet up with our daughter and her husband as we had not seen them in three years, I was very excited!! We walked the waterfront and shopped in tourist shops…always a fun time, took selfies, and had a great dinner. I had to stop and rest a couple of times but did OK.


They came and stayed with us for a little over a week, such a fun time, we drove south to Bandon, shopped the tourist shops again, drove up in the mountains took pictures of sunsets, and drove to Shore Acres, an hour from us on the high rocks over looking the Pacific Ocean…had a great time. I was always conscious of how I was feeling…made sure I took sit down breaks, I had enough to eat to keep up what strength I had, and laughed a lot; always makes you feel better.
Laughter is medicine for the Soul!





Pictured above is a Family Fun Day at a local swimmng park. It is a popular place, weathers always warm with little wind. We were lucky we were the only ones there. Fun relaxing place with the highlight of jumping into the “bathtub” and pool of very warm water. Tucker, our dog loves it as well. The rope swing is popular. It has a large area to just float. Great Day!
BEACH DAY!!!!!


As most of you know who read my blog, the beach is my favorite place!
There is peace at the beach. The sound and beauty of the surf, sand, sky, birds, driftwood, all in it natural habitat. Each time you go it’s always different…different shells, driftwood, clouds, tide/surf, sun, fog…alwys something different to see.
Also a positive result, I decided to stop all supplements for a couple of days to see if something I am taking I have developed a sensitivity to. Always an issue. I did feel better so now starting back on them one at a time. So June was also a good month…family activities, changing my health supplement protocol, my chelation infusion, and a hormone test. So I can have more energy, and I will be stronger, I will have energy, I will feel balanced, I will ride my bike this summer, I will go tubing, and most important, I will be happy:)
What I learned this month (MAY)…Heavy metal & Mycotoxins testing, “A glimmer of hope”
may 31,2025

May was a hard month with Chronic fatigue, the strides I have made the last two years….still feeling fragile but able to walk a couple times a day, shop at the store, drive short distances in my small town, feeling hopeful… if I keep progressing I will be able to have some independance and get a portion of my life back!! However, in the middle of May my legs became weak, not able to rebuild the energy I was using when walking in the morning. I couple of times I felt faint, weak and lightheaded. This became more consistant so I started walking in the afternoon when my husband, Steve, could go with me…my walking distant became shorter and shorter, some day not walking at all. I was getting very frustrated. I wasn’t able to keep up on cleaning and cooking. I was getting very exhausted. Eating clean and healthy didn’t make a difference. I was having to sleep once or twice a day.
I made an appointment with a functional medicine doctor. She wanted to do testing of Mycotoxins and Heavy Metal testing. I was a little apprehensive as I had done this already 4 years before(I had high levels of mercury)…I detoxed twice six month per detox, felt stronger up until now. But I ordered the test kit to rule toxins out. Two days ago I got the results. The blue dots in red are at High risk. The blue dots in orange are moderate risk.

Out of 50 mycotoxins & heavy metals I have six “at risk” and eight “moderate risk”. Starting from the top Bisphenol is plastics – cause fertility problesm, male impotence, heart disease, cancers(prostrate, breast).
Lead-highly heavy metal – nearly every organ, targeting the brain and central nervous system, leading to coma, convulsions, and death. Not Cool!
AflatoxinB1-a toxin drastically affects the liver, carcinogen causes liver damage as it is implicated in Hepatitis B and hepatocarcinoma.
AflatoxinB2-hepatocarcinogen – hepatocarcinogenesis is the process which liver cancer, specifically hepatocedllular caracinoma developes, a step by step process where normal liver cells(hepatocytes) undergo changes that lead to uncontrolled cell growth and the formation of cancerous tumors….chronic liver damage.
AflatoxinM1-human carcinogen, it can cause liver damage, immune suppression, internal haemorrhaging, muscle tremors, and impact gain and efficiency. Can come from contaminated milk…I don’t drink milk…
FumonisinsB1-hepatotixic and nephrotoxic, which means induction of oxidative stress, apoptosis, and cytotoxicy, and alterations in cytokine expression, Leukopena, sepsis, bone marrow supression, hemosidersosi, and multple haemorrhages…. All is NOT good!! Not sure how I got any of these….
I talked to my functional medicine doctor on Monday for recommendations. Chelation this Wednesday…will be to rid the body of Lead but not sure with the rest of these….thankful there was a cancelation otherwise it wouldn’t be until January as she is having shoulder surgery. I couldn’t of went that long…feeling so weak and sick. She told me that with the high level of Lead, my system was not able to rid itself from other toxins. At this point my cells are disregulated and not functioning properly. I can tell as I have felt weaker/sicker for about two months. Also my hormones are not balanced so I did labs yesterday and will talk to that functional medicine doctor July 9th. My “Glimmer of Hope” is after eliminating the heavy metals, and mycotoins, I will get some strength back!!!
On the Positive Note!


I was able to watch and take pictures of our grandson’s baseball home games, felt well enough to watch Oregon State Beaves Baseball in Corvallis, go on mountain drives and take pictures of all the wildflowers and as we were coming off the mountains we were able to see the sun set through the trees!
These are the activities that keep me going, keep me trying, keep me working on my health. So much of my health journey is surviving the day with energy to accomplish my daily goals . Everyday is a new day, always hoping the next day I will feel better, stronger… eating healthy to feel stronger. I still have my 20 minute excersise routine in the morning, keeps my legs, core, arms, and back strong. Jumping on my rebounder helps my balance.





Pictures to the right are the trip we took to Bandon. I didn’t feel good that day, but I hoped that as we traveled the hour to Bandon I would feel better and feel stronger. However, I didn’t, as we walked down the main street in Bandon a was feeling a little light-headed I wanted to go to other stores, expecially the Cranberry Sweet store where they have all kinds of sweet samples…chocolate!! After having two samples of Rocky Road Fudge, I did feel better! I thought “Cool” now I can walk with stability. When I am tired/light-headed I have trouble walking in a straight line. So for the rest of the time in downtown Bandon I did fine.

But of course I wanted to go to the beach. All the beaches in Bandon you have to walk down long flights of stairs, (equivalent to 3-4 flights) I was fine and took pictures, but back up the stairs I could tell my legs were weak again. I stopped several times on the way up to rest my legs. I went home and did NOTHING…hoping I didn’t overdue and have an adrenal crash. Unfortunately, I woke up in the night with aching legs, upset stomach, and achy all over…Adrenal Crash. I felt the effects for six days.
It’s really hard as I want to get out and do fun things. Most of my time is spent in my home where I can sit down and rest and I can pace myself on home projects…doing only so much per day. Sometimes at home I do too much and feel the “crash”. The hard part is I never know when I have done too much until it too late…usually hours later. I hope when I get the lead and mycotoxins gone I will have more enetrgy. “Feeling Hopeful“!! I will be better, I will have more energy, I will be able to ride my bike, I will be able to go on walks again, I will be able to travel to see our family again!!!
Posted May 6, 2025

APRIL 2025–The Challenge of living with Chronic Fatigue Syndrome
I was diagnosed with Chronic Fatigue Syndrome (CSF)seven years ago. However, I have had on and off episodes of CFS for 45 years, around the time our 4th child was born. I was SO tired. No one knows what causes it as it could have many, such as food allergies, chemical toxicity, gut biosis, poor immune system, high levels of heavy metals or molds in your system, mycotoxins, environmental chemicals, auto immune diseases, etc. The list is endless. Keep in mind you could have more than one reason why you have CFS. Finding the root cause is the hardest part. Living with the fatigue for an extented period of time the fatigue becomes chronic…the longer you live with the fatigue, not knowing the cause the body becomes stressed, inflammed, then exhausted…hence chronic fatigue.
What is Chronic Fatigue syndrome – my experience is an overwhelmming feeling of extreme exhaustion and lethargy, often without warning or a reason even after adequate sleep. You can feel good for a few days then for no known reason feel bad for several…complete fatigue. On your “good days” feeling good, however; doesn’t mean you can run, hike miles, ride bike, work a full day of work as you still have NO sustained energy. Even on good days you HAVE to rest several times. If you don’t then you could become sick with flu like symptoms for several days..the crash. For me it’s the Adrenal Crash. So tired to even talk, move, eat, or breath. Sleeping doesn’t help as you will wake up just as tried until the body has rested enough, around 7 days, to build back from the cause of the crash.
The Adrenal Fatigue Crash
In advanced stages of Adrenal Fatigue Syndrome AFS, the body crashes as fatigue becomes overwhelming, and many other clincial symptoms can worsen such as hypoglycemia, low blood pressure, fluid and electrolyte imbalance, anxiety, insomnia, and irregular heart rate…ME The crash is the body’s cry to replenish the reserve at the cellular level, because it has been automataically reduced to the lowest physiologically sustainable levels as the body moves closer to Adrenal Failure. A point we have depleted the energy reserves…ME

This last month has been one of my hardest months…in the first week I got flu/covid with its fatigue, painful head and body aches, slight fever which lasted two weeks. I felt I was getting better, however, headaches came back again. After several days of Tylenol, I realized I had a sinus infection which also causes me extreme fatigue. After a few days into the medication I then also got a yeast infection. Sigh… My functional medicine doctor highly adviced me to cut out eating fruit and all natural sugars as she feels this is one of the reasons for my on going exhausting fatigue as well. In doing so this has also caused another level of fatigue. Currently I don’t have the energy to walk Tucker (our grandson’s dog) to our local park…which I have done for the last two years. Hope to get that level of energy back!

After I recovered from the illnesses, except for the lingering fatigue, my husband and I took a Saturday and drove to a beach south of us, walked a couple blocks of the town and went to a couple of beaches. I was tired but ok. It was a great day! I rested the remainder of the evening. However, 2:30 in the morning I woke up to burning legs and skin, extreme fatigue, and upset stomach, flu like symptoms ( an Adrenal Crash) which usually last 5-7 days. Apprently I over did, I am on day 4 of the adrenal crash. ocasional burning legs and skin and still very tired no sustainal leg strength.
The Hardest part of Chronic Fatigue Syndrome CFS
“The hardest part? Feeling like you’re completely alone You can feel exiled… Most friends don’t understand
Some will say you’re faking it. Other will say that you’re depressed. Sometimes to your face, other times or behind your back or “your sick only when it’s convenient.” Hard to explain to people why you don’t feel well when you don’t even know why youself.
It’s a tiredness that is hard to explain…too tired to process information, breath, move, stand for any length of time, “Don’t ask me any questions…I’m too tired to think.” Sometimes all you want to do is sleep, sometimes it’s the only thing you can do.
The hardest part is I can never make a committment as I never know how I am going to feel, I can’t count on myself…I have wasted several plane tickets, sports game tickets, dentist appointments, disappointing family, and for not being able to travel to see family.( we only go where we can drive) and lunch dates with friends. I would like to have the option to have a job , even a part time job,
I’ve been told “there’s nothing we can do, enjoy your good days.” WOW, like I have any.
I want real answers, real stories and a real shot at moving forward.
You’re not sure you believe recover is possible, but you wish you could end up spending $$$$$$$$ on Doctors and supplements to feel better and trying to find someone who can help.


The left picture I don’t look tired in this picture, however, I was, tired enough for my balance to be off. This was the beach trip… the night I got sick with an adrenal crash. The picture to the right I felt good enough to go ride and I drove first to show my grandson where to go, but I felt weak and shaky as I was using more energy than I had. When I let him drive I could just sit and I felt much better. I always take a selfie when I go places and see if I look tired…I have learned how to not look tired. I want to look healthy/happy:) I don’t want to be remembered as always feeling and looking tired. But sadly when I look back I can always remember… JUST BECAUSE I LOOK FINE…DOESN’T MEAN I FEEL FINE!!!..Let me repeat this again “JUST BECAUSE I LOOK FINE…DOESN’T MEAN I FEEL FINE!!! …I have spent a life time pushing myself and faking normalcy when I am exhausted.
Currently we have tickets to watch a college baseball game. Will we be able to go??? I won’t know until that day. For me mornings are the hardest…I wake up tired. As the day goes on I hope to have more energy. Summer is just around the corner.

I want to ride our polaris over the dunes and mountain roads, swim, go tubing, hike to see waterfalls and beautiful country, feeling the freedom of running again, visit family, go crabbing in our boat…not having to worry how I am going to feel or feel good enough to go.
I have a new functional medicine doctor. She wants to do testing and looking at my current tests. Already she can see I don’t have enough cortisol. I have some adrenal supplements coming. and a low mg of progestrone (the first was 100 mg and made me feel sick) so she knows we have to go slow. I am hopeful the testing will give me more answers. She has some other protocols she wants to try…in time. I’ll keep you posted! If anyone reading this has Chronic Fatigue Syndrome I would love to hear from you… I don’t know anyone who has CFS. I would like to know your stratagies, tricks and fixes that help you.
My only option is to keep on working on my journey of health.

Clean eating, 1/2 cup of fruit a day, lots of vegetables, protein, excersise/walk when I feel well enough, be open minded to all suggestions, and follow them 100%. I continue to have a positve attitude on life…I focus on what I can do verses what I can’t do. I try to accomplish something everyday… calling a family member to see how they are doing. I have a great garden and I am looking forward of buying flowers for the yard. Definitely looking forward to summer and spending time in the sun! Excited to seeing family this summer…these are the best times:)Summer has many fun activities and looking forward to all of them. Think positive, stay positive, be positve, think positive again, and accomplish something positive everyday!
My dinner this evening. Ingredients: Lettece, beet greens & cilantro from the garden, sliced cucumbers, purple onion slices, chopped celery, tomatoes, shredded beet root from the garden, black beans, bacon, and goat cheese (senitive to all milk products), 1 lime squeezed, and one avacodo diced. Dressing Organic honey ginger vinaigrette. Yum!
Have a Great Month!!
What I learned this month
April 10, 2025

Minerals are like the unseen foundation upon which our health is built
March — came with its challenges for sure. It was such a wet month…so much rain on the Oregon coast. The picture below to the right is a field where there usually is a herd of elk next to highway 38.

I managed most days to keep my committment to walk every morning with our grandson’s dog, Tucker, however, I started feel this overwhelming tiredness all the time. I always felt I needed to sit down and rest as I walked Tucker around the park, lightheadedness was becoming an issue. I had a couple of nearly fainting episodes as well…always hoping tomorrow I’d feel better. Too tired to cook. I started having to take naps once a day sometimes twice a day. Feeling very frustrated in survial mode of WHY?
In February I had starting reading a book “The Rain Barrel Effect,“ by Dr. Stephen Cabral, which included an insert to have a FREE TOXICITY/MINERAL ASSESSMENT. So why not! Ordered the testing kit, when it came I cut two little bunches of hair, placed it in the box and sent it back.

Results – – No Heavy Metals in my system…Hurray!!! A year ago I did two detoxes to rid my body of Mercury and any all other heavy metals. However, my Sodium, Potassium, Iron, Zinc, Chromium, Selenium, Phosphorus, Manganese were all down in the bottom in the “red zone.” Symptoms of lacking minerals are allergies, apathy, dizziness, exhaustion, poor digestion, fatigue, and imbalanced blood pressure…I had all of these symptoms! So I started taking mineral immediately and within a week my legs felt stronger, more mental energy, and stopped burning and aching all over, and I was sleeping better. I am still taking the minerals but not as big as doses.
The minerals in our diet are essential to feel your body is solid…functioning propertly to mentally process clearly. They are important for building strong bones and teeth, blood, skin, hair, nerve function, muscle and for metabolic processes such as those that turn the food we eat into energy.



Just like vitamins, minerals help you stay healthy. The body uses minerals to perform many different functions — from building strong bones to transmitting nerve impulses. Some minerals are even used to make hormones or maintain a normal heartbeat. A balanced diet rich in fruits, vegetables, whole grains, lean protein, and dairy products can provide the necessary minerals. Specific sources for some key minerals include:
Macrominerals:
- Calcium: Essential for bone and teeth structure, muscle and nerve function, and blood clotting.
- Phosphorus: Works with calcium to build strong bones and teeth, and is involved in energy production.
- Magnesium: Important for muscle and nerve function, blood sugar control, and bone health.
- Sodium: Helps maintain fluid balance in the body and is essential for nerve and muscle function.
- Potassium: Also important for fluid balance, nerve function, and muscle contraction.
- Chloride: Helps maintain fluid balance and plays a role in nerve function and digestion.
- Sulfur: A component of proteins and other important molecules in the body.
Trace Minerals:
- Iron: Essential for carrying oxygen in red blood cells.
- Zinc: Important for immune function, wound healing, and enzyme activity.
- Copper: Needed for energy production, immune function, and nerve function.
- Iodine: Essential for thyroid hormone production, which regulates metabolism.
- Selenium: An antioxidant that helps protect cells from damage and supports immune function.
- Manganese: Involved in bone formation, energy production, and enzyme activity.
- Fluoride: Helps prevent tooth decay and strengthens tooth enamel.
I was lacking at least 7 of these essential minerals. If you are struggling with fatigue AT any level get your minerals checked.

Even though on my hard tired day/weeks this month, I am determination to be outside on sunny days; mentally uplifting for me are the mountains to witness the new growth of spring and taking walks in the sun or beach time when the sun sets. These are My favorite places to be. They are my happy places. In my daily struggle to feel good; the mountains and the beach refreshes my soul with a sense of peace when amoung huge timbers, spring wild flowers and the crashing waves… music to my ears.



Yes, March was a hard month but most important I was able to find the problem and move past another stumbling block, a new awareness of my health journey.
Take minerals… Learning about wellness is a lifetime process and for me, I will continue in my search/quest until I have sustained energy. Then with my knowledge this will be my life path…Eternal Health. We are happier when we have some control of our life, our health. Do something everyday for your health, walk, run, ride a bike, stretch, resistance training, eat fresh vegetables, healthy protein, fresh juice, fresh fruit, get early morning sun, breathe fresh air everyday, and get good sleep until it becomes a habit:) Your body will thank you!
March 1, 2025

February 2025 is one of those months when I am glad when it is over…usually our wettest, windest, cold weather on the coast. Where our house is located, we don’t get sun from November – February…always in the shade of the hill from trees above us. I struggle in the winter months to have sustainable energy.

When I go for my daily walks, this is when I get the sun on my face, so I walk every day. The flu I thought I had in January (included in last months post) were allergic reactions, which also include lightheadedness ( came close to fainting a few times) For some reason my system became weaker and more sensitive to some foods and chemicals I have tolerated for years. For example, L-Lysine, fish oil (for my omega 3s) chia seeds, nutritional yeast, olive oil, all milk products (made my stomach nausous) laundry soap that I have been using for years, dish washer pods. After eliminating these items I was a little better. I wasn’t sick all day, but still exhausted and dizzy. I also have to keep in mind the vegtables and fruits maybe organic but that doesn’t mean that that they weren’t containated another way, such as the field they were grown in could of been grown by a highway, washed with chorine in the water, fertilizers not 100% organic, etc. I am not able to eat organic strawberries, grapes, some vegetables or pistachios(this is why I grow my own garden). Just pulled my last carrots out yesterday.
As I child when I was tested I was allergic to my own dander, so I always change my sheets once a week. Not only did I change my sheets but I vaccumed and dusted my bedroom and mattress and flipped it over, which I hadn’t done for a while. I felt a little better again. Short lived…I became exhausted and sick all day long AGAIN!!
I’m extremely exhausted in the mornings until late afternoon everyday. Usually feel more solid and have energy at night. I have taken my blood pressure and sugar levels many times…they are fine.
I questioned whether I would be strong enough to travel and see family this month…a 9 hour trip one way. My hope was with the change of schedule, where I sleep, dryer air, and different house, I hoped to feel better and I did!!!



I went shopping, had lunch with my grandchildren, took a hike in the snow on our families property…I was gone all day. I felt much better on our trip.
Even in mornings I felt better. The room I slept in when visting family didn’t have a TV… so maybe the electromegnetic waves from the TV in my room at home was causing my fatigue. It’s always a guessing game and has been for 50 years…have to keep trying…
Took out the TV when we got back home; unfortunately, it didn’t make a difference. So tonight I’m not even going to sleep in my room…see if I can feel better tomorrow…fingers crossed. I have to have some reprieve…I swear if it’s not raining I’ll sleep outside! LOL
YES…better today…still tired, but bouncing back faster. I walked this morning but tired ( I had to sit and rest before I could walk and not eat much as eating will make me feel sick if I am chemically loaded. So drink to flush it out! Even though this month was exhaustly hard, I force myself to get out everyday; movement…being active is key…Thankful I live in a beautiful place. Fingers crossed March will be a better month. I will tell myself every moring…”I will feel strong today!”



In sharing my monthly health journey you know you are not alone in your struggle, whether it is physical, emotional, mental…it’s all a fight. Stay positive, move forward, call a friend, walk in the sun, lay in the sun, watch an inspirational movie, tomorrow is a new day, with new possibilities, new opportunities, people to connect to and places to see. The stuggle is real but we can do it together:) We are warriors.
February 1, 2025
January has been a tough one. Contacted an intestinal flu which made me super tired, nauseated, stomach tenderness. I had this 4 times each time 5 days. I finally got over it by eating chopped garlic daily and Ivermectin for 1 1/2 weeks. Then I had to build my strength back; however had trouble sleeping, which has been a on going issue of mine. Last night was the worst. Today I was exhausted and had to sleep a couple of hours.

I have made a committment to myself, that if all possible, I will walk everyday. My husband, Steve, and I got out of the house and walked down town by the rivers edge. It was a calm evening…I love to take pictures so took reflection pics. This makes me happy, fulfulled, at peace with nature…so healthy/healing for me physically and mentally.

Taking pictures gives me purpose. I am not able to do as much as I use to…so taking pictures is therapeutic. Helps make to use my creativity when finding the best shot then editing the picture. Helps to take the focus off how I feel and on a positive activity.

This would be my advice to anyone with a chronic illness, no matter what it is, try to do something positive each day. Take a walk, walk your dog, go outside and just enjoy the view (the sun, trees, water, flowers) call a friend, a relative, keep a journal, listen to music, learn an instrument (playing music is refreshing and rewarding) watch a funny movie…laughing is music to the soul. I hope you find your happy place, activity, or person who can help you continue on your journey of wellness with grace and positivity.
Remember your health includes many different aspects of your life, physical, emotional, psyhological, mental, spiritual; a life time process to wellness. All takes time, comittment, energy and work. My hope is to let you know your are not alone in this journey
January 2025

Begining a new year I always have hopes, goals, accomplishments I want to achieve. Even though my health journey is going on it 7th year with many ups and downs…many times of exhausting fatigue, I also know this year will be filled with many fun times. Many outdoor walks, family chats, family get togethers, vacations, sun filled summer days, and birthday and holiday celebrations. I like the quote by Eleanor Roosevelt, ” With a new day comes new strength and new Thoughts.” Each day we have the opportunity to start the day with “Today will be a good day and I will be happy and grateful for being here.” Each day I try to have a positive thought for myself. Today’s thought was, ” I will be stronger today than I was yesterday.”
I was able to go to one of my favorite places…the beach. It is my happy place. It was the first time in two week I felt good enough to go. I appreciate all the beauty it has to offer. I restores my soul. I hope you have a place you can go and feel relaxed and at peace with your self and your surroundings. I feel the energy of the beach/waves. Find your peaceful place…a place to heal physically, emotionally, mentally, psychologically, and spiritually. You will feel your energy restored, find clarity and peace.


October/November/December 2024
I’ve taken a vacation from my blog due to health issues. When I think I have my health under control, kind of like a remission, I get hit again. In October I spent a week with my daughter and her family. Two days went great but then I started waking up sick…very tired and lathargic. The weather was still nice to spent as much outside as I could. I became more exhauted. I concluded something in the house I was reacting to. I was eating my own food, my own water, sleeping in cotton bedding…etc, however, still feeling very sick. I would feel a little better at night. I even tried sleeping in different rooms of the house to see if something in the bedroom was bothering me. After staying a week I had a flight on Wednesday but was too sick/fatigued to make my flight, which was depressing to me, as I knew I would be sick until Saturday when my husband was driving 8 hours to take me home. I don’t know what was in the home that I was so sensitive to…I can only guess???

Very frustrating…took me a couple of weeks to get my energy back. Halloween I managed to carve a pumpkin!
November was a good month, walking daily, family coming for Thanksgiving, but always dealing with a level of fatigue. I wanted to ride my bike before the weather got wet and cold, and our ATV out on the dunes, but I never felt strong enough before winter came with rain, wind, and cold temperatures.
Still eating AIP diet (Anti-inflamatory diet Protocal ) very healthy. My grandson shot an elk…I was so excited!!!!

Now we have elk meat to eat and elk bones for making bone broth!!! It is the best meat!!! Makes the bests bone broth! Since I am sensitive to beef, chicken, pork and fish (mercury), I’ll have a great source of protein!
Thanksgiving vacation was good as we also had several families come. Since our kids know I struggle with health issues they brought food and helped in the preparation. The day after Thanksgiving I felt well enough to go Heceta Lighthouse and walk the trails. It is a spectacular beautifulj place on the Oregon coast. It was especially nice to be able to go with family and grandkids!


Needless to say when I got home I was tired. Glad we had so many left overs to eat!
December is always busy with decorating. I have to do it in phases…slowly a room per day so I don’t over do. On the 10th of December I got a flu bug…or I thought…still not sure, with lasted 5-7 days. I got back into walking my grandson’s dog, Tucker, and finish decorating, baking, shopping, etc. Christmas was great with family.

Steve and I went down to Shore Acres to see all the Christmas lights. They are always amazing!!! However the day after Christmas I got sick with the same flu bug again. Down another 5-7 days. Missed our Idaho flight to Idaho to spend the New Years with family. I was bummed. Currently in January I have had this flu three more times. Symptoms are nauseousness, super tired you just want to sleep, sensitive stomach and stomach cramps. After getting having these “flu like episodes two more times and an entire night of my stomach hurting all night I went to ER and got two series of blood test, CT scan on my abdomen, as I have been so tired, nauseous and crampy for three weeks. The good news blood test were good and cultures were negative.
I was so tired of feeling tired and sick, I had not left the house for a week and a half, so I started on Ivermectin for a virus and chopped fresh garlic, ginger, cloves daily for parisites. I will posted how I feel in a couple more days. Fingers crossed I feel better…trying to cover all bases…
November 2025
I have been feeling better the last few days…always a good thing! I had my doctors appointment today and since all my labs are good he is referring me to an endocrinologist. I am excited about this direction! At seventy years old I think it is time to check my endorcrine system.

The endocrine gland system functions releasing hormones from various glands into the bloodstream, which then travel to different parts of the body to regulate a wide range of bodily processes in cluding growth, metabolism, mood, reproduction, and organ function…acting as a chemical messenger system to maintain hormeostasis with the body.
Pituitary gland: Produces hormones line growth hormone, thyroid stimulating hormone (TSH), and adrenocorticotropic hormone (ACTH)
Thyroid gland: secretes thyroxine and triiodothyronine, regulates metabolism.
Adrenal glands: Release cortisol, the stress hormone.
Pancreas: Produces insulin and glucagon to control blood sugar levels.
Pineal gland: produces melatonin, a hormone that regulates sleep and circadian rhythms.
Hypothalamus: is a part of the grain that produces hormones that regulate many bodily functions…to maintain a homeostasis state in the body.
Body Temperature
Hormone production
Heart rate
Hunger
Mood
Sex drive
Sleep
Thirst
With this information above I realize I have many of these issues. So I am excited!!! Keep you posted!
May 22, 2024
I live three miles from the Pacific Ocean so weather is not always warm. Todays weather was overcast with some sun. My grandson has a dog so I take him on a 40 minute walk on paths around the park most every day rain or shine… . Some days I can walk without stopping …most days I have to sit for a rest. This has mentally helped me in contining to keep positive in my health journey. I also love to walk the beach it does wonders for my mind! Always uplifting and gives me peace. Picture below is walking Tucker at the park.

As I mentioned on an earlier post for 40 years I was a distant runner. On work days I would be running by 5:30 running a loop around our small town. A run which took around 45 minutes. I ran in many local races, and coached cross county and track for many years. I try NOT TO COMPARE!
Sometimes I catch myself thinking sad/negative thoughts of I’ll never get better…I still have so many limitations, and always still so tired. In a zoom meeting Positive Mindset , the Coach made a statement, ” Comparison is the thief of joy.” I have thought of this statement a lot and have used it in other situations other than my health; however, personally – it’s in my mind every day.
After 4 years when I first felt strong enough to walk again I could only walk one block up from our house, another year later two blocks, then three. After my first detox I could then make it four blocks to the park only and back. Then after sometime I could walk to the park and around one small path circle…then it was two. Currently I can walk to the park, around the large and small circle and home, I still have to take rests…somedays more than others. Am I satisfied where I am…no, but I am improving; I am stronger, but not yet strong…I will get there!
If you Google “The Power of Positivity” the overview quotes, “Positive thinking can help people cope with stress, have better immunity, and have lower risk of premature death. It can help promote greater feeings of happiness and overall satisfaction with life.” A positive outlook can help me feel more motivated, receive more inspiration regarding my health issues, easier to feel happy regardless of what is happening in my life besides phyical health…an over all feeling of well-being.
We all want threads of hope. In a mindset of happiness these threads come much easier. Everyone’s happiness “tricks” are different. “My tricks” get outside, take a walk, think of everything you have in your life, think about your special friend/family, think of one positive thing that happend yesterday. Make something happen today!


My favorite places to be… the beach and in the mountains. I feel lucky to live by these two beautiful places!
Exercise & Movement
As a distant runner averaging 30 miles a week to not running at all and many days not getting off the couch. I hated to feel my body go from strong/strength to weak loosing all my muscle tone. The mercury in my system had affected all parts of my system…my adrenal glands, digestive system, skipping heart, headaches, disfunctioning microbiome, hormone inbalance, because of low immunes system epstein barr virus numbers were high as the body was fighting them as well.
In my search for wellness I listened to Dr. Mark Hyman talk about his recovery. He stressed the importance of movement. He also had mercury toxicity which had caused other health issues. He would tell himself to get off the couch and do something. This I could so relate to…everytime after I ate I was, and many times still, so tired with a feeling of exhaustion. I give myself fifteen minutes, then I do something…walk, ride my exercise bike, yard work, etc.

I live on a hill so at first I could only walk down and up one time for 3 1/2 years and I could always stretch to keep my muscles limber. I felt this gave me some control of myself and not letting the fatigue totally control me. Once I connected with my online medical group and started the AIP diet while doing my 1st detox for toxins and heavy metals I struggled with increase fatigue while detoxing. It took me twice as long as others to get through the program, but I still was able to finish after 7 months. I did feel stronger and I was able to walk up and down my hill 4 times and I was able to drive again.

This Christmas I got a rebounder with a counter and this has helped with my endurance and balance. I started at 80 jumps. After 6 months I jump 700-900. I play a couple of “Abba” songs…some days I jump 400 bounces (usually one song) some days I can jump 2 songs 800 bounces. Some days I am not able to jump at all…all depends on how well I slept the night before and how much energy I have.
April 2024
When you have a bad day…JUMP!
Rebounding is a low-impact cardiovascular exercise. Strengthens abdominal, leg, back, arm muscles and helps drain the lymphatic system. Helps to improve balance, coordination and endurance. Also, it may help flush out toxins, bacteria, dead cells, and other wastes. You can personalize your own routine at your own level and take breaks when ever you need to…it’s all at your level. I could see a difference after the first week in my balance, strength in my legs, and arms.
So my schedule is – energy permitting
Morning – Rebounding, push ups or sit -ups, leg stretching, then walk our grandson’s dog, Tucker, for 30-40 minutes. Later in the evening I will do 20 leg extensions with weights. To some this may seem like too much and to others not enough. You have to find what you can do. Remember, all I could do was stretch for 3+ years. So important in the healing process. My excersise gives me a sense of control, drains my lymph glands, increases my heart rate, I get fresh air everyday and sun most days walking Tucker. I didn’t let the fatigue win…I won! Begin, progress, consistent, resilience, achieve.
The benefits of exercise by Mark Hyman, “Strength training improves your mood, helps prevent dementia, increases neuroplasticity, makes new brain cells, improves muscle strength, your bone health so it can stave off osteoporosis and prevent you from being frail as you get older. It helps with sleep.”
Dr. Mark Hyman is the senior advisor for the Cleveland Clinic’s Center for

Functional Medicine, board president for clinical affairs for the Institute for functional Medicine, he is the host of one of the leading podcasts, The Doctor’s Farmacy. Author of several books, “The Pegan Diet; Food Fix; Eat Fat, Get Thin; and Young Forever and several more.
He has so many awesome podcasts. https://drhyman.com/blog/category/podcasts/You can pick the podcasts you would like to hear for your own personal health. Very inspiring, educational, modivational…everything you need to know about health in all aspects. The knowledge you learn will be a game changer!
“When everything seems to be going wrong, take a minute to remind yourself of all the things going right”
I remind myself of this everyday. Two years ago I started writing a daily journal with ONLY positive entries. At first the entries were only a sentence. The longer I journaled the longer the posts. This helped me see ALL the positives in my life. I woke up this morning, I am a living breathing person, I have family I talk to everyday, the sun was shining today, walked today, plenty of food to eat, clothes to wear; An attitude of gratitude is a healthy approach to life.
In the book written by Josh Axe, Think This Not That, he makes this statement in his book many times, for example “THINK THIS: I can because…NOT THAT: I can’t because…” Believing in ourselves “We can” gives us the power to do whatever it is our goal to achieve whether it is a journey of health, job promotions, or develop a new skill. Believing in ourself gives us a sense of purpose. it is the single greatest power in determining what our future will be.
If we are comsummed by negative beliefs, think for a moment why and where these are coming from, then change to a positive statement, then make steps to make it happen. It’s not about what happened to us…it’s we believe in ourselves and our inner capabilities that determines our destiny.

Leave a comment